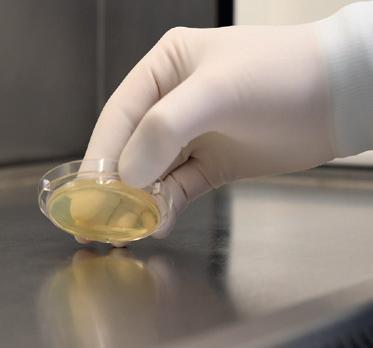

VENTILATIE-EFFECTIVITEIT EN EFFECTIEF VENTILEREN IN CLEANROOMS


SIGNIFICANTE REDUCTIE VAN DE ENERGIEVRAAG IN OPERATIEKAMERS EFFECT VAN EEN KLEEFMAT OP LUCHTREINHEID EN DEELTJESDEPOSITIESNELHEID












DISCOVER MORE.

![]()


























VENTILATIE-EFFECTIVITEIT EN EFFECTIEF VENTILEREN IN CLEANROOMS


SIGNIFICANTE REDUCTIE VAN DE ENERGIEVRAAG IN OPERATIEKAMERS EFFECT VAN EEN KLEEFMAT OP LUCHTREINHEID EN DEELTJESDEPOSITIESNELHEID












DISCOVER MORE.

Beste lezer,
Oud en nieuw lijkt nog zo kortgeleden, maar toch zijn we alweer aan het einde van de derde maand van 2025. VCCN is het jaar positief begonnen. Zo is er een groei in het aantal persoonlijke- en bedrijfsleden zichtbaar en zijn er interessante plannen voor kennisoverdracht en nieuwe activiteiten.
In dit eerste nummer van het Contamination Control Magazine in 2025 heeft de redactiecommissie weer interessante artikelen op het gebied van contamination control en cleanliness verzameld. Van twee onderzoeken worden de resultaten gepubliceerd. Allereerst het onderzoek van het Landelijk Netwerk de Groene OK ten aanzien van het energiegebruik van luchtbehandelingssystemen op operatiekamers. En als tweede worden de resultaten gegeven van het onderzoek naar het gebruik van kleefmatten op de luchtreinheid en de deeltjesdepositiesnelheid.
Daarnaast is er nog een artikel dat uitgebreid ingaat op het begrip ventilatie-effectiviteit in cleanrooms en wordt het tweede artikel over productreinheid verificatie aan de binnenzijde van een product.
Kortom een uitgave waarin meerdere sectoren aan bod komen. Met het verschijnen van dit nummer heeft VCCN ook het eerste grote congres achter de rug. In dit nummer is een verslag opgenomen van de Cleanliness Day van 11 maart. Een succesvolle dag waar een grote groep professionals bijeen kwam om kennis op te nemen en uit te wisselen over product cleanliness.
Maar, 2025 heeft meer in petto met het Nationaal Symposium Contamination Control in mei en het Contamination Control Congres in het najaar. Dit naast een geplande excursie naast ASML en andere minisymposia. Details over deze activiteiten worden uiteraard gedeeld in dit magazine maar voor de laatste stand van zaken verwijs ik ook graag naar onze website en de nieuwsbrief.
De redactieraad wenst jullie veel leesplezier.
Jos Bijman


VENTILATIE-EFFECTIVITEIT EN EFFECTIEF VENTILEREN IN CLEANROOMS
In dit artikel wordt het begrip ventilatie-effectiviteit in cleanrooms besproken. Geconcludeerd wordt dat de enige juiste grootheid de contamination removal effectiveness is. Een belangrijkere conclusie is dat ventilatieeffectiviteit een leuk theoretisch concept is, maar dat het in de praktijk vooral zaak is te kiezen voor robuuste luchtverdeelontwerpen. Een van de mogelijke varianten is de tot heden vrijwel niet in cleanrooms toegepaste thermische verdringing. Hiermee zijn zeer hoge ventilatie-effectiviteitwaarden te realiseren. Dit kan zorgen voor substantiële besparingen in luchthoeveelheden en daarmee ook in investeringen en operationele kosten.
Door: Ron Houtenbos, Consultant/eigenaar Induventus

Het Landelijk Netwerk de Groene OK voert een onderzoek uit naar het energiegebruik, van luchtbehandelingssystemen, op de operatiekamers. In dit artikel worden de eerste resultaten gepresenteerd.
Door: dr. Jos Lans, Dr. Ing. Roberto Traversari MBA, Ir. Wim Maassen EngD, Ing. Gerbrand van Middelkoop en Drs. Sandra Lako

EFFECT VAN EEN KLEEFMAT
OP LUCHTREINHEID EN DEELTJESDEPOSITIESNELHEID
In een operationele industriële cleanroom is onderzocht wat het effect is van het gebruik van een kleefmat bij de ingang van een cleanroom op het beheersen van contaminatie via de vloer.
Door: Koos Agricola, Brookhuis Applied Data Intelligence & Olof Teulings, NTS

PRODUCTREINHEID VERIFICATIE: DEELTJES CONTAMINATIE (DEEL 2)
In een eerder artikel (Contamination Control Magazine september 2024) over dit onderwerp is uitgebreid ingegaan op de problematiek van het meten van deeltjes verontreiniging aan de binnenkant van een product. De gangbare meettechnieken waarmee je deeltjesverontreinigingen op oppervlakken kunt meten schieten hierbij tekort, omdat de oppervlakten aan de binnenkant van het product niet toegankelijk zijn voor deze technieken.
6 VENTILATIE-EFFECTIVITEIT EN EFFECTIEF VENTILEREN IN CLEANROOMS
Door: Ron Houtenbos, Consultant/ eigenaar Induventus
14 SIGNIFICANTE REDUCTIE VAN DE ENERGIEVRAAG IN OPERATIEKAMERS
Door: dr. Jos Lans, Dr. Ing. Roberto Traversari MBA, Ir. Wim Maassen EngD, Ing. Gerbrand van Middelkoop en Drs. Sandra Lako
20 EFFECT VAN EEN KLEEFMAT OP LUCHTREINHEID EN DEELTJESDEPOSITIESNELHEID
Door: Koos Agricola, Brookhuis Applied Data Intelligence
26 PRODUCTREINHEID
VERIFICATIE: DEELTJES CONTAMINATIE (DEEL 2)
Door: Paul Krüsemann, Eurofins Materials Science NL
33 CURSUS UITGELICHT
Post-hbo opleiding Contamination Control & Cleanliness
34 SUCCESVOLLE VCCN CLEANLINESS DAY
Door: Jos Bijman , Kennismanager VCCN
39 EEN DAG UIT HET LEVEN VAN... Maurice Adriaans, Projectdirecteur Equans Zuid Nederland BV
40 CURSUSSEN 2025 / EVEN VOORSTELLEN
Door: Paul Krüsemann, Eurofins Materials Science NL





In dit artikel wordt het begrip ventilatie-effectiviteit in cleanrooms besproken. Geconcludeerd wordt dat de enige juiste grootheid de contamination removal effectiveness is. Een belangrijkere conclusie is dat ventilatie-effectiviteit een leuk theoretisch concept is, maar dat het in de praktijk vooral zaak is te kiezen voor robuuste luchtverdeelontwerpen. Een van de mogelijke varianten is de tot heden vrijwel niet in cleanrooms toegepaste thermische verdringing. Hiermee zijn zeer hoge ventilatie-effectiviteitwaarden te realiseren. Dit kan zorgen voor substantiële besparingen in luchthoeveelheden en daarmee ook in investeringen en operationele kosten.




In de NEN-EN-ISO-14644-16 [1] wordt de term ventilatie-effectiviteit gebruikt. De manier waarop dit begrip wordt toegepast, leidt in de praktijk realistisch gezien eerder tot meer dan tot minder energiegebruik. In dit artikel worden de termen ventileren en ventilatie gebruikt, terwijl in cleanrooms circuleren en circulatie beter op z’n plaats zouden zijn. Alle termen worden door elkaar gebruikt.
Door: Ron Houtenbos, Consultant/eigenaar Induventus
Wat is ventilatie-effectiviteit? Daar begint direct al een probleem: er zijn diverse definities in omloop. Anderzijds is de definitie eenduidig af te leiden van de manier waarop er met ventilatieeffectiviteit wordt gerekend. In Annex A van NEN-EN-ISO 14644-16 wordt de formule gegeven waarmee het benodigde debiet in een niet-UDF ruimte kan worden berekend:
Qs = D ε•Cr (1)
met:
Qs = luchtdebiet [m3/s]
D = deeltjesverspreiding [-/s] ε = ventilatie-effectiviteit [-]
C r = maximaal toelaatbare deeltjesconcentratie in ruimte [-/m3]
Bij de deeltjesconcentratie [Cr] wordt de aanname gedaan dat er een verwaarloosbaar aantal deeltjes in de toevoerlucht aanwezig is (HEPA filter).
Deze formule kan herschreven worden naar:
ε = D QS•Cr (2)
De concentratie Cuit in het uitgaande kanaal is:
Cuit = D QS (3)
Uit formule 2 en 3 volgt:
ε = D QS•Cr = Cuit Cr (4)
Wat de norm met ventilatie-effectiviteit bedoelt, is dus de verhouding tussen de concentratie in het uitgaande kanaal en die in de ruimte. Deze grootheid staat bekend als de contamination removal effectiveness (CRE). Voor het bepalen van CRE is de positie en aard van de vervuilingsbronnen van essentieel belang.
Vervolgens zien we in veel artikelen en presentaties een heel andere definitie toegepast worden: de air change effectiveness (ACE). Om het lastig te maken, kent deze grootheid twee definities; één volgens REHVA en één volgens ASHRAE. Om de ACE in de cleanroompraktijk te kunnen toepassen is het noodzakelijk om uit te gaan van de definitie volgens ASHRAE. De REHVA-definitie leidt tot uitkomsten die een factor 2 kleiner zijn. Volgens ANSI/ ASHRAE Standard 129-1997 (RA 2002) [2] is ACE gedefinieerd als:
ACE = τn /τi (5)
met:
ACE = Air Change Effectiveness [-]
τn = nominale tijdconstante [s]
τi = luchtleeftijd op positie i in de ruimte [s]
Hier doet zich het probleem voor dat vrijwel geen enkele ontwerper zich iets kan voorstellen bij de term luchtleeftijd (age of air). Gelukkig is door Whyte c.s. [3] aangetoond dat formule 5 geheel identiek is aan formule 6:
ACE = lokaal effectiefcirculatievoud circulatievoudvanderuimte = N Nruimte (6)
Het lokaal effectief circulatievoud is af te leiden uit de lokale hersteltijd; de tijd om de stofconcentratie op een positie in de ruimte met een factor 100 te laten dalen. Het circulatievoud van de ruimte volgt uit de luchthoeveelheid gedeeld door het volume van de ruimte. Uit de definitie blijkt dat de aanwezigheid en dus ook locatie van stofbronnen geen enkele rol speelt bij de bepaling van ACE.
ACE VERSUS CRE
De definitie van ACE is dus wezenlijk anders dan die van CRE. CRE volgens formule 4 geeft de kwaliteit van afvoeren van verontreiniging aan, terwijl ACE volgens formule 6 een maat is voor de snelheid van verwijderen. Toch wordt door diverse auteurs de waarde van ACE als ε in formule 1 ingevuld. Dan zal ten minste de waarde van CRE en ACE (ongeveer) hetzelfde moeten zijn. Is dit te verwachten? Als voorbeeld kijken we naar een ideale UDF-stroming (plunjerstroming), omdat we daar de waarde van zowel CRE als ACE kunnen beredeneren. Direct bij de intrede van de ruimte is de luchtleeftijd bijna nul. ACE zal daar dus nagenoeg oneindig zijn. De waarde daalt via een machtsfunctie naar 1 bij de uittrede van de ruimte. CRE begint ook met een oneindig grote waarde. Zolang er geen vervuiling is, blijft dat zo. Bij het passeren van de vervuilingsbron (veelal de mens) daalt de waarde snel naar 1. Uit figuur 2 blijkt dat de waardes van CRE en ACE niet per definitie gelijk aan elkaar zijn. Ze zullen dat alleen zijn als de vervuilingsbronnen gelijkmatig over de ruimte verdeeld zijn.
2: Verloop van de contamination removal effectiveness (CRE) en air change
(ACE) in een UDF-stroming.
BELANGRIJK
ARGUMENT IS HET FEIT DAT IN EEN CLEANROOM
MENSEN MEESTAL DE GROOTSTE
VERVUILINGSBRON ZIJN.
Novoselac & Srebric [4] hebben voor diverse ventilatiestrategieën de verschillen tussen ACE en CRE met behulp van CFD berekend. Zie figuur 1 voor resultaten hiervan. Hieruit blijkt dat de getalswaarden van ACE en CRE goed overeenkomen voor mengventilatie, maar dat deze bij verdringingsventilatie een grote spreiding vertonen. Deze resultaten bevestigen het beeld dat uit figuur 2 oprijst. Er worden in de literatuur verschillende voordelen van het gebruik van ACE als maat voor de ventilatie-effectiviteit aangedragen [4] , [5]. Een belangrijk argument is het feit dat in een cleanroom mensen meestal de grootste vervuilingsbron zijn en dat die over het algemeen geen vaste positie in de ruimte hebben. Dat maakt het gebruik van CRE minder praktisch. Een tweede genoemd voordeel van ACE is dat deze kan worden bepaald op basis van de hersteltijdmetingen die toch al tijdens de kwalificatiewerkzaamheden dienen te worden uitgevoerd. Dit lijken valide argumenten voor het gebruik van ACE. Verderop in dit artikel komen we er nader op terug.
VERMINDERING
VENTILATIE-EFFECTIVITEIT
DOOR DEPOSITIE
Niet alleen de stromingsvorm, maar ook het neerslaan van zware deeltjes beïnvloedt de waarde van de ventilatie-effectiviteit. De afname van de deeltjesconcentratie door verdunning wordt weergegeven door de formule:
C (t) = C0 • e-nt
met:
(7)
C(t) = concentratie op tijdstip t [-/m3]
C0 = concentratie op tijdstip t=0 [-/m3]
n = circulatievoud van de ruimte [-/s]
t = tijd vanaf begin verdunning [s]
Grotere deeltjes zullen niet alleen door de luchtcirculatie, maar ook door depositie uit de ruimtelucht verdwijnen. Formule 7 wijzigt daardoor in:
C (t) = C0 • e-λt
λ = n + k (8)
met:
λ = afnamesnelheid (decay rate) [-/s]
n = circulatievoud van de ruimte [-/s]
k = virtuele aantal circulatievouden t.g.v. depositie [-/s]
Het virtuele aantal circulatievouden ten gevolge van depositie (k) volgt uit:
k = vD h (9)
met:
vD = depositiesnelheid voor deeltjes ≥ D [m/s]
h = ruimtehoogte [m]
In Houtenbos [6] is de volgende formule voor de depositiesnelheid afgeleid, die een uitbreiding is van een formule afgeleid door Whyte c.s. [7] en geldig is tot
D = 100:
vD = 0,0202 • D1,656 • ( C Cref ) 0,0024D-0,24 (10)
met:
vD = depositiesnelheid voor deeltjes ≥ D [m/s]
D = deeltjesgrootte [μm]
Cref = concentratie waarbij Whyte c.s. [7] hebben gemeten [-/m3]
Alle deeltjes die neerslaan op oppervlakken in de cleanroom, worden niet met de lucht afgevoerd. De concentratie in de afvoer zal daardoor een factor n/(n+k) kleiner zijn dan zonder depositie het geval was geweest. Dat betekent dat de effectieve CRE dan gelijk wordt aan:
ε * = C*uit Cr = n ⁄ (n+k) • Cuit Cr = n n+k • ε (11)
met:
ε* = ventilatie-effectiviteit (CRE) in de situatie met depositie [-]
Cuit* = concentratie in het afvoerkanaal in situatie met depositie [-/m3]
C r = concentratie in de ruimte [-/m3]
ε = ventilatie-effectiviteit (CRE) in de situatie zonder depositie [-]
In figuur 3 is de afname van de contamination removal effectiveness t.g.v. depositie weergegeven voor verschillende luchtwisselingen en deeltjesgrootten bij een aangenomen ruimtehoogte van 3m en CRE = 0,9 zonder depositie.
Deze gecorrigeerde ε* dient te worden gebruikt bij berekening van het benodigde debiet wanneer er een maximale deeltjesneerslag (deposition rate) in deeltjes/(m2•s) voor deeltjes ≥ 1 μm wordt gevraagd. Wanneer er een maximale concentratie wordt gevraagd in deeltjes/m3, dan kan de normale CRE worden gebruikt. De depositie zorgt dan als het ware voor een ‘gratis’ aantal extra luchtwisselingen.
In figuur 4 zijn schematisch diverse stromingsvormen weergegeven met hun typische CRE-waarden. Links staat de UDF-stroming met een CRE die theoretisch oneindig groot is. Daarnaast de stroming die bekend staat als thermische verdringing. Hier zijn waarden mogelijk in de ordegrootte CRE = 10. Dan de bekende mengstroming met de theoretische CRE = 1. Als laatste de in principe ongewenste kortsluitstroming met CRE < 1. Deze stroming is ongewenst, omdat een deel van de lucht ongebruikt naar de afvoer stroomt en dus niet aan de menging in de ruimte meedoet. De ruimteconcentra-
gecorrigeerde
n= 2/h
n= 5/h
n= 10/h
n= 50/h
Deeltjesgrootte D [µm]
tie wordt dus hoger dan in het geval van menging.
Goed beschouwd is dit laatste echter de situatie die in menig non-UDF cleanroom wordt aangetroffen, als er is gekozen om (een deel van) de toevoerlucht direct vanuit het eindfilter, zonder rooster, in de ruimte te brengen. Daardoor ontstaat een verticaal naar beneden gerichte straal die veel minder mengt dan wanneer met een inducerend rooster wordt uitgeblazen. Het gevolg is CRE > 1 in deze straal (dus schonere lucht). Het gevolg is wel CRE < 1
in het gebied buiten de straal, met hogere concentraties tot gevolg.
In figuur 5 is het kerngebied in de luchtstraal schematisch weergegeven. In dit gebied bevat de lucht nagenoeg geen deeltjes. Rondom dit kerngebied vormt zich een turbulente mengzone, waar omgevingslucht zich mengt met de schone toevoerlucht. De schone kernzone wordt daardoor steeds kleiner. De typische lengte van de kernzone is zo’n 1,5 maal de afmeting van het filter [8]. Daaronder is geen volledig schone lucht meer in de straal aanwezig. Op een afstand van
Unidirectioneel
2 maal de kernlengte bedraagt de concentratie in de straal al zo’n 75% van de gemiddelde ruimteconcentratie. Als het doel van het weglaten van een inblaasrooster is om een extra schone zone in de cleanroom te maken, dan is dat dus alleen effectief wanneer zo’n inblaasopening voldoende groot is. En bedenk dat in het restant van de ruimte de concentratie omhooggaat. Hoewel in de straal CRE > 1 is, is buiten de straal CRE < 1. Als overal in de ruimte dezelfde stofklasse is vereist, is er dus niet minder, maar juist meer lucht nodig!
Een andere veel voorkomende wijze van lucht toevoeren in een non-UDF cleanroom is via Filter Fan Units die in een dambordpatroon in het plafond zijn gelegd. De uitblaassnelheid ligt typisch tussen 0,3 en 0,5 m/s. Onder deze units vormen zich ook stralen zoals in figuur 5. De turbulente mengzone breidt zich niet alleen naar binnen toe uit, maar ook naar buiten. Geïnduceerde omgevingslucht wordt versneld. Dit gaat ten koste van de snelheid van de primaire lucht. Gevolg is een steeds grotere hoeveelheid lucht in de straal met een steeds lagere snelheid: de doorsnede van de straal moet dus toenemen. Als gevolg hiervan zullen de individuele stralen elkaar
Filter
Kerngebied
Turbulente mengzone
Omgevingslucht
BUITEN.
gaan raken (figuur 6). Vanuit symmetrieoverweging zal dit ook op ca. 1,5 maal de diameter van de unit gebeuren.
De geïnduceerde lucht verdwijnt hier weer uit de straal en stroomt retour naar boven. Gevolg is dat onder die hoogte er een soort van UDF-stroming ontstaat met een gemiddelde snelheid die de helft is van de uitblaassnelheid. Deze snelheid is echter niet voldoende om een thermische stroming boven een warmtebron als een persoon om te buigen [9]. Als gevolg hiervan zal er menging ontstaan, waarbij de mate van menging afhankelijk is van de hoeveelheid en kracht van de aanwezige warmtebronnen. Een stroming die in potentie een zeer hoge ventilatie-
effectiviteit kan opleveren, zal dit in de praktijk dus niet doen.
Voor het gebruiken van CRE (contamination removal effectiveness) als maat voor de ventilatie-effectiviteit volstaat één argument: het is de enig juiste definitie conform NEN-EN-ISO 14644-16. Voor het niet gebruiken van ACE (air change effectiveness) zijn verschillende argumenten:
• De waarden kunnen sterk afwijken van die van CRE. Alleen in het geval van mengventilatie stemmen de waarden goed overeen. Beide grootheden hebben dan ongeveer de waarde 1.
Je kunt je afvragen welke zin het gebruik van ventilatie-effectiviteit dan heeft: een correctie met 1 is per saldo geen correctie.
• Het gebruik van ACE zou een voordeel zijn gezien het feit dat in een cleanroom mensen meestal de grootste vervuilingsbron zijn en dat die over het algemeen geen vaste positie in de ruimte hebben. In dit artikel is aangetoond dat de luchtstroming in ruimten die door zwak inducerende toevoer van lucht worden voorzien, grotendeels door warmtebronnen (vaak mensen) wordt bepaald. Dan valt dit vermeende voordeel van het gebruik van ACE dus weg.
• Het argument dat ACE te bepalen is uit hersteltijdmetingen die tijdens validatie toch al moeten worden uitgevoerd is waar. Maar wat ook zo is, is dat CRE te bepalen is uit de concentratiemetingen die toch al moeten worden uitgevoerd. De enige extra benodigde meting is een concentratiemeting in de afvoer, bij voorkeur vlak voor de ventilator.
Uit bovenstaande voorbeelden kunnen we concluderen dat ontwerpkeuzen die lokaal een hoge ventilatie-effectiviteit opleveren, dat over de ruimte gemiddeld juist niet realiseren. De hogere waarde van
de ventilatie-effectiviteit suggereert dat er minder lucht nodig zou zijn. Het tegendeel is echter het geval. Het advies is daarom te kiezen voor robuuste ontwerpen. Wanneer een ruimte met mengventilatie wordt ontworpen, kies dan voor luchttoevoer via goed inducerende roosters. Als plaatselijk een betere stofklasse nodig is, kies dan voor een goed afgeschermd mini-environment met naar keuze een UDF of mengende luchttoevoer.
Als alternatief voor mengventilatie kan ook voor thermische verdringing worden gekozen. Dit is mogelijk in ruimten waar warmtebronnen aanwezig zijn. Hoewel deze vorm van verdringing (zie het plaatje ‘Stratificatie’ in figuur 4) in veel gevallen een zeer goed alternatief is voor mengsystemen, is de belangstelling hiervoor gering. Zoals Detzer [10] in een artikel in TVVL Magazine in 2005 al schreef: “De resultaten die in vele industriële bedrijven en ook in grootkeukens met dit concept zijn behaald, bevestigen de juistheid van de keuze voor thermische verdringing volledig. Bij ventilatiesystemen voor cleanrooms kan men ervan uitgaan dat de zuiverheid van de lucht in het onderste deel van de ruimte tot een factor 10, d.w.z. een volledige stofklasse, beter is
dan bij mengstromingen met dezelfde volumestroom van de toevoerlucht”. Een ventilatie-effectiviteit van 10 opent de mogelijkheid tot substantiële reductie van de luchthoeveelheden!
[1] NEN-EN-ISO 14644-16 (2019), Stof- en kiemarme ruimten en omgevingen - Deel 16: Praktijkcode voor de verbetering van energie- efficiëntie in stof- en kiemarme ruimten en schoon luchtapparatuur, NEN, 2019
[2] ANSI/ ASHRAE Standard 129-1997 (RA 2002), Measuring Air Change Effectiveness, ASHRAE , 1997
[3] Whyte, W. et al., 2014. Decay of airborne contamination and ventilation effectiveness of cleanrooms. International Journal of Ventilation, 13(3), pp.211–220.
[4] Novoselac, A. & Srebric, J., 2003. Comparison of air exchange efficiency and contaminant removal effectiveness as IAQ indices. Transactions - American Society of Heating Refrigerating and Air Conditioning Engineers, 109(2), pp.339–349.
[5] Whyte, W. et al., 2018. Ventilation effectiveness in cleanrooms and its relation to decay rate, recovery rate, and air change rate. European Journal of Parenteral and Pharmaceutical Sciences, 23(4), pp.126–134.
[6] Houtenbos, R., 2024. Deeltjesdepositie nader beschouwd. Contamination Control Magazine, 37(3), pp.12–18.
[7] Whyte, W., Derks, M. & Agricola, K., 2016. Airborne particle deposition in cleanrooms: Relationship between deposition rate and airborne concentration (2/3). Clean Air and Containment Review, 25, pp.4–10.
[8] Kriegel, M. et al., 2017. Eneff: Reine RäumeOptimierung von Luftströmungen bei minimalem Energieeinsatz, TU Berlin, Hermann-Rietschel Institut.
[9] Hofer, V., 2019. Zum kontaminierten Raumvolumen von Partikel-und Wärmequellen in laminarer Verdrängungsströmung. Technische Universität Berlin (Germany).
[10] Detzer, R., 2005. Ontwerp van ventilatiesystemen voor cleanrooms. TVVL Magazine, (2), pp.55–58.
Environmental Monitoring Waarborging van Kwaliteit en Veiligheid
Environmental Monitoring (EM) in cleanrooms is van cruciaal belang om de kwaliteit en veiligheid van producten te waarborgen, vooral in de farmaceutische industrie. Cleanrooms zijn streng gecontroleerde omgevingen waarin de luchtkwaliteit, temperatuur, vochtigheid en de aanwezigheid van deeltjes zorgvuldig moeten worden gemonitord om de veilige productie van farmaceutische producten te waarborgen. De richtlijnen van de Annex 1 van de EU GMP (Good Manufacturing Practice) leggen strikte eisen op aan de omgevingen, inclusief cleanrooms, om de productie van steriele farmaceutische producten te waarborgen. Eurofins Bactimm B.V. is een GMP gecertificeerd laboratorium met expertise in het ondersteunen van farmaceutische producenten bij hun EM-activiteiten, om te waarborgen dat omgevingen voldoen aan de geldende regelgeving.
Maar waar begin je en hoe zorg je ervoor dat je voldoet aan de EU GMP Annex 1?
Het begint allemaal met het opzetten van een duidelijk, efficiënt, kosteneffectief en GMP conform EM-programma. In dit programma moet worden beschreven hoe aan de regelgeving wordt voldaan en welke parameters gemonitord moeten worden om de kwaliteit en veiligheid in de productieomgeving te waarborgen. Essentiële parameters zijn onder andere het aantal deeltjes, microbiologische contaminatie, temperatuur en vochtigheid. Eurofins Bactimm ondersteunt van begin tot eind: van het opzetten van het programma en het afnemen van monsters op locatie (on-site sampling) tot het analyseren van de genomen monsters op microbiologische veiligheid.
Meer vragen over Environmental Monitoring en hoe te voldoen aan de EU GMP Annex 1 richtlijnen?
Neem contact met ons op info.EBPT-NL@bpt.eurofinseu.com of bezoek onze website www.eurofins.nl/bpt
Eurofins Bactimm B.V. Eurofins BioPharma Product Testing Netherlands














Het Landelijk Netwerk de Groene OK voert een onderzoek uit naar het energiegebruik, van luchtbehandelingssystemen, op de operatiekamers. In dit artikel worden de eerste resultaten gepresenteerd. Dit onderzoek wordt gefinancierd vanuit het Ministerie van Volksgezondheid, Welzijn en Sport (VWS) op basis van de Urgenda agenda maatregel 51. Na de eerste publicatie van het onderzoek in het Contamination Control Magazine van maart 2024 worden in dit artikel de belangrijkste resultaten van de tweede fase van het onderzoek weergegeven.




ALLE OPERATIES
Ziekenhuizen en andere zorginstellingen in Nederland hebben een Green Deal duurzame zorg ondertekend om hun afvalproductie te minimaliseren, minder energie te gebruiken en acties te ondernemen om duurzamer te worden. In 2030 moet de CO2-uitstoot ten minste 55% lager zijn dan in 1990 en in 2050 moeten alle zorgorganisaties CO2neutraal zijn. Een flinke besparing is te bereiken in de operatiekamer.
Door: dr. Jos Lans, Dr. Ing. Roberto Traversari MBA, Ir. Wim Maassen EngD, Ing. Gerbrand van Middelkoop en Drs. Sandra Lako
De operatiekamer afdeling is een van de meest energie-intensieve afdelingen van een ziekenhuis. Het merendeel van de operatiekamers in Nederland heeft een luchtbehandelingsinstallatie met een ultra-clean ventilatiesysteem (UCV) Klasse 1+ dat zorgt voor een uitgekiende luchtstroming met behulp van een groot aantal lucht wisselingen per uur. Niet alle operaties vereisen echter een ultra-clean operatiekamer.
De tweede fase betrof de periode van juni 2024 tot en met augustus 2024 waarin er metingen werden verricht aan het luchtbehandelingssysteem van negen operatiekamers. Dit betrof operatiekamers bij
drie academische ziekenhuizen, drie perifere ziekenhuizen en twee privéklinieken.
Deze operatiekamers zijn geografisch verdeeld over Nederland. De temperatuur en relatieve vochtigheid van de luchtstroom voor en na de verschillende componenten in de luchtbehandelingskast en ook het opgenomen vermogen van de ventilatoren zijn hierbij gemeten. Deze referentieset aan operatiekamers bestond uit systeemtypologie B (vier locaties) en systeemtypologie C (vijf locaties), zie voor deze systeemtypologieën figuur 1.
Op basis van de uitgevoerde metingen en de gegevens verkregen uit de enquête (Contamination Control Magazine maart 2024) is het besparingspotentieel van de energiebehoefte in kaart gebracht.
Make-up air (MUA)
Operatiekamer
Systeemtypologie A
Make-up air (MUA)
Recirculation air unit (RAU)
Operatiekamer
Systeemtypologie B
Recirculation
Make-up air (MUA)
Operatiekamer
Systeemtypologie C
Figuur 1: Systeemtypologieën luchtbehandelingssysteem voor operatiekamers.
De CO2 uitstoot is in dit onderzoek niet beschouwd, omdat de opwekking en de levering van de energiebehoefte van de luchtbehandelingsinstallaties buiten de scope van dit onderzoek vallen. Om het energiebesparingspotentieel te bepalen is gebruikgemaakt van een rekenmodel waarbij waarden afgeleid uit metingen als invoer zijn gebruikt. Er is een referentiesituatie gedefinieerd en vervolgens zijn scenario’s met maatregelen doorgerekend om de jaarlijkse besparingen in de energiebehoefte te bepalen.
Om de potentiële energiebesparing van maatregelen te bepalen is gebruik gemaakt van een referentiesituatie.
De aangehouden referentiesituatie is gebaseerd op de resultaten uit de enquête en metingen die zijn uitgevoerd, en heeft de volgende kenmerken.
De relatieve vochtigheid was bij 57% van de respondenten ingesteld tussen de 50-65%. Het gemiddelde buitenlucht aandeel (ODA) bedroeg ongeveer 2.700 m3/h en de totale luchthoeveelheid (SUP) ongeveer 8.600 m3/h. De operatiekamers in de referentieset hadden een gemiddelde hoeveelheid verse buitenlucht van 2.367 m3/h (min. 1.000 - max. 3.000 m3/h) en een hoeveelheid aan de operatiekamer toegevoerde hoeveelheid van 9.691 m3/h (min. 3.000 -15.129 m3/h). De referentieset bestond uit zeven klasse 1+ operatiekamers en twee klasse 1 operatiekamers. De aan de operatiekamer toegevoerde luchttemperatuur bedroeg gemiddeld 19,7 °C (min. 19,0 - max. 21,2 °C) en de temperatuurverhoging in de operatiekamers was 0,9 °C (min. 0,0 - max. 2,1°C).
Ondanks dat een groot deel van de respondenten (80%) in de enquête hebben aangegeven maatregelen te hebben genomen om de luchttechnische installatie gedurende de nacht en in de weekenden terug te schakelen, hebben wij voor een referentiesituatie gekozen waarbij de
installatie continu volledig aan staat. Deze keuze hebben wij gemaakt omdat 20% van de respondenten de installatie nog niet uitschakelt en dit een goede en realistische referentiesituatie is waaraan de andere maatregelen (scenario’s) kunnen worden relateert.
Vergeleken met de referentiesituatie werd het energiebesparingspotentieel voor verschillende scenario’s bepaald. De vier realistische scenario’s die zijn beschouwd betroffen:
1. Scenario A
Waarbij de grenzen voor de relatieve vochtigheid worden verruimd[1]. De relatieve vochtigheid werd gewijzigd van 50-65% naar 30-70%.
2. Scenario B
Het overschakelen naar een stand-by modus wanneer de operatiekamer niet in gebruik is, 's nachts of in het weekend[2]. De bedrijfsuren werden gewijzigd van 00:00 h - 24:00 h, weekend aan naar 07:00 h - 18.00 h, weekend uit.
3. Scenario C
Verlaging van de hoeveelheid ODA [3,4]. De ODA werd verlaagd van de oorspronkelijke ontwerpwaarden tot 1.000 m3/h tijdens bedrijfsuren en 500 m3/ in stand-by en in het weekend.
4. Scenario D
Verlaging van de totale toevoerlucht (SUP) die in de operatiekamer wordt ingebracht [5]. De SUP werd ingesteld op 3.000 m3/h (conventionele operatiekamer, Klasse 1).
Voor de reductie van de hoeveelheid toegevoerde verse buitenlucht is uitgegaan
van het minimaal vereiste niveau uit de Arbo-catalogus inhalatie anesthetica en voor de ruimere grenzen voor de relatieve vochtigheid is aangesloten bij de verduurzamingskaart van het expertisecentrum verduurzaming zorg.[6]
Om van een OK klasse 1+ naar een klasse 1 te gaan is uitgegaan van een hoeveelheid aan de operatiekamer toegevoerde lucht van 3.000 m3/h. Uitgangspunt hierbij is dat met deze luchthoeveelheid aan de eisen van een Klasse 1 wordt voldaan (circulatievoud ≥ 20 en ISO deeltjes klasse 7 volgens NEN-EN-ISO 14644-1). In de benadering hebben we aangehouden dat de temperatuur toename in de operatiekamers bij het terugbrengen van de luchthoeveelheid (van klasse1+ naar klasse 1) gelijk blijft.
Deze aanname betekent dat we uitgaan van een lagere interne warmtelast bij een Klasse 1 operatiekamer. In sommige situaties kan de ondersteuningsverwarming die bij klasse 1+ bedrijf gebruikt wordt om het temperatuurverschil te realiseren niet nodig is bij een Klasse 1, waardoor een aanvullende energiebesparing ontstaat.
Over het algemeen hebben ingrepen die uitgevoerd mogen worden in een klasse 1 operatiekamer een hogere apparatuurwarmtelast dan een klasse 1+. Aandachtspunt is dus of bij reductie van de luchthoeveelheden het koelvermogen nog voldoende is. In sommige situaties kan het reduceren van de luchthoeveelheid betekenen dat de ondersteuningsverwarming die bij Klasse 1+ bedrijf nodig was niet meer nodig is. Dit levert een extra energiebesparing op. Deze ondersteunings-
verwarming wordt soms gebruikt om het benodigde temperatuurverschil (tussen toevoer- en ruimtetemperatuur) voor een goede luchtstroming te realiseren of om het comfort te verbeteren.
De berekende, gemiddelde besparingen voor de scenario’s ten opzichte van de referentieset zijn hieronder weergegeven.
Scenario A: De relatieve vochtigheid gewijzigd van 50-65% naar 30-70%.
De benodigde hoeveelheid thermische energie wordt door het verruimen van de grenzen voor de relatieve vochtigheid met gemiddeld 33% gereduceerd.
Scenario B: De bedrijfsuren gewijzigd van volledig aan naar van 07:00 h - 18.00 h aan en weekend uit.
Door de luchtbehandelingsinstallaties van operatiekamers ‘s nachts of in het weekend, door bijvoorbeeld kloktijden, terug te zetten naar een lager niveau kan er 41% thermisch, respectievelijk 60% elektrisch/ mechanisch, worden bespaard.
Scenario C: De ODA verlaagd van de oorspronkelijke ontwerpwaarden tot 1.000 m3/h tijdens bedrijfsuren en 500 m3/ in stand-by en in het weekend.
Wanneer de hoeveelheid ODA tijdens en buiten werkuren wordt teruggebracht tot respectievelijk 1.000 en 500 m3/h, daalt
Energie besparingspotentieel (thermisch)
Energie besparingspotentieel (elektrisch/mechanisch)
Scenario A, Relatieve vochtigheid [30-70%]
Scenario B, Kloktijden [07:00-18:00] Weekend UIT
Scenario C, ODA [naar 1.000 m³/h]
Scenario D, SUP [naar 3.000 m³/h]
de energievraag met gemiddeld 53% thermisch en 49% elektrisch/mechanisch.
Scenario D: De hoeveelheid toevoerlucht aan de operatiekamer (SUP) ingesteld op 3.000 m3/h (conventionele operatiekamer, Klasse 1).
Het terugbrengen van de operatiekamer classificatie, van klasse 1+ naar klasse 1 operatiekamer, zorgt voor een elektrisch/ mechanische besparing van 36%.
Figuur 2 geeft de boxplot weer van het besparingspotentieel voor zowel de thermische - als voor de elektrische/mechanische energie van de ventilatoren voor de referenieset ziekenhuizen als de scenario’s worden doorgevoerd.
Energie besparingspotentieel Ultra-Clean en algemene/coventionele OK (thermisch)
Energie besparingspotentieel Ultra-Clean en algemene/coventionele OK (elektrisch/mechanisch)
(Klasse 1, alle scenario’s) Ultra Clean (Klasse 1+, alle scenario’s)
Figuur 2: Potentieel voor thermische energiebesparing per scenario (2.a). Potentieel aan thermische energiebesparing voor een Ultra-Clean en algemene conventionele luchtbehandelingsinstallatie voor operatiekamers bij implementatie van alle scenario’s (2.b). Potentieel aan elektrische/ mechanische energiebesparing per scenario (2.c). Potentieel aan besparingen op de vraag naar elektrische/ mechanische energie voor een Ultra-Clean en algemene luchtbehandelingsinstallatie voor operatiekamers bij uitvoering van alle scenario’s (2.d).
De beschreven besparingsmogelijkheden zullen (indirect) de CO2 voetafdruk van de luchttechnische installatie op de operatiekamerafdeling verminderen. De CO2 voetafdruk kan naast de luchttechnische installatie ook worden verminderd door het verlagen van de uitstoot van inhalatieanesthetica, een transitie naar de inkoop van circulaire goederen en het verminderen van de afvalproductie door ‘reduce’, ‘reuse’ en ‘recycle’.
Veel operatiekamers lijken onnodig gebouwd als ultraclean operatiekamer en het ODA-volume dat in de operatiekamer wordt geïntroduceerd is relatief hoog. Het is bij luchtbehandelingsinstallatie typologie C relatief eenvoudig schakelen tussen de classificatie van de operatiekamer van een klasse 1+ naar een klasse 1 en vice versa.
Voordat een bestaande luchttechnische installatie wordt aangepast is het van belang te weten hoe deze is opgebouwd.
Bij veel ziekenhuizen wordt de primaire luchttechnische installatie niet alleen voor de operatiekamer gebruikt. Andere ruimten binnen het operatiekamercomplex zijn hier veelal aan gekoppeld. De toenemende vraag naar energiebesparing vereist een luchtbehandelingssysteem dat de veranderende vraag aankan.
In ziekenhuizen worden al de nodige maatregelen genomen om het energiegebruik van het luchtbehandelingssysteem in operatiekamers te reduceren. De meeste ziekenhuizen maken gebruik van warmteterugwinsystemen om energie uit de afgevoerde luchtstroom terug te winnen. Ook wordt de luchthoeveelheid in de nacht en weekenden bij 80% van de respondenten al gereduceerd.
Er zijn verschillende manieren om energie te besparen in bestaande operatiekamers
met betrekking tot het luchtbehandelingssysteem. Energiebesparing kan worden gerealiseerd door de hoeveelheid ODA te verminderen, de installatie in stand-by modus te zetten als de OK niet in gebruik is, het bereik (onderste en bovenste setpoint) van de relatieve luchtvochtigheid te vergroten en de classificatie van de operatiekamer te verlagen van ultraclean (klasse 1+) naar algemeen (klasse 1).
Het verlagen van de ODA heeft een groot effect op energiebesparing ten opzichte van de referentiesituatie. Het verlagen van ODA is in bestaande faciliteiten vaak niet eenvoudig. Hiervoor moet eerst worden onderzocht wat de mogelijkheden zijn op basis van het technische ontwerp van het luchtbehandelingssysteem.
Relatief eenvoudige aanpassingen om energie te besparen zijn onder andere het verruimen van de relatieve vochtigheidslimieten, het invoeren van operationele kloktijden en het verlagen van de operatiekamerclassificatie. Het verlagen van de operatiekamerclassificatie heeft in deze studie het minste invloed op het energieverbruik ten opzichte van de gedefinieerde referentie situatie. Met het installeren van een eenvoudige bewegingssensor kan ook overdag de ventilatie worden verlaagd als de operatiekamer niet in gebruik is.
Er blijkt nog veel potentie te zijn voor energiebesparing en de uiteindelijk beoogde CO2 -uitstoot reductie te rea-
liseren door één of meerdere van de genoemde maatregelen door te voeren.
1. TNO en TU/e in opdracht van NFU en NVZ. (2021). Bevochtigingseisen in de zorghuisvesting praktijk.
2. Traversari, A. A. L., Bottenheft, C., van Heumen, S. P. M., Goedhart, C. A., & Vos, M. C. (2017). Effect of switching off unidirectional downflow systems of operating theaters during prolonged inactivity on the period before the operating theater can safely be used. American Journal of Infection Control, 45(2), 139-144. https://doi.org/10.1016/j.ajic.2016.07.019
3. Schweizerischer Verein von Gebäudetechnik-Ingenieuren. (2015). SWKI VA10501 Raumlufttechnische Anlagen in medizinisch genutzten Räumen SICC VA105-01 www.swki.ch
4. DIN 1946-4: 2018-09. (2018). Ventilation and air conditioning - Part 4: Ventilation in buildings and rooms of health care
5. Lans, J. L. A., Mathijssen, N. M. C., Bode, A., van den Dobbelsteen, J. J., van der Elst, M., & Luscuere, P. G. (2024). What is the effect of reducing the air change rate on the ventilation effectiveness in ultra-clean operating rooms? J ournal of Hospital Infection. https://doi.org/10.1016/ j.jhin.2024.02.007.
6. Expertisecentrum Verduurzaming Zorg. (2023). Bevochtigingseisen in ziekenhuizen. www.expertisecentrumverduurzamingzorg. nl/wp-content/uploads/2023/04/ Verduurzamingskaart-Bevochtigingseisenin-ziekenhuizen-V1.0.pdf





Luchtkwaliteit monitoring in de Gezondsheidzorg
Zorg voor een gezonde lucht in uw zorginstelling met de Palas AQ Guard.
Deze geavanceerde luchtkwaliteit monitor biedt real-time monitoring van de lucht in ziekenhuizen, klinieken en zorginstellingen. Detecteer schadelijke deeltjes en waarborg een optimale luchtkwaliteit voor patiënten en medewerkers.
Betrouwbaar, nauwkeurig en eenvoudig te integreren in uw gezondheidszorgomgeving.
Fijnstof vanaf een deeltjesgrootte van 0,15 μm, meting van CO en berekening van de luchtkwaliteit index en 2 infectierisico-indicator
Bescherm gezondheid, verbeter welzijn –met de Palas AQ Guard.















In een operationele industriële cleanroom is onderzocht wat het effect is van het gebruik van een kleefmat bij de ingang van een cleanroom op het beheersen van contaminatie via de vloer. In plaats van het onderzoeken van de verwijderingsefficiëntie van een kleefmat is de impact op de reinheidsniveaus in een cleanroom bepaald. Het onderzoek toonde een hoge reductie van de deeltjesconcentraties in de lucht en deeltjesdepositiesnelheden door het gebruik van kleefmatten. De geteste Dycem polymere mat was effectiever dan de geteste afpelmat.


De beheersing van contaminatie in een personensluis op vloerniveau is belangrijk om de meesleep van deeltjes naar de cleanroom te beperken. Maatregelen om de overdracht van deeltjes, waaronder microbe dragende deeltjes, door schoeisel van buitenaf naar de cleanroom te verminderen bestaan uit frequente reinigen van de vloer en het toepassen van kleefmatten. Kleefmatten worden onderverdeeld in twee groepen: afpelbare kleefmatten, waarvan ieder vel na gebruik wordt weggegooid en permanente wasbare polymere matten (Dycem). Vaak bedekken polymere matten een groter gebied dan afpelbare matten.
Er zijn diverse onderzoeken gepubliceerd over de verwijderingsefficiëntie voor micro-organismen en deeltjes van schoeisel met behulp van polymere kleefmatten van Dycem (zie [1] en [2]). Zowel antimicrobiële eigenschappen als deeltjesverwijdering geven goede resultaten bij het verminderen van de overdracht van micro-organismen via een kleefmat. Er zijn geen onderzoeken gepubliceerd naar de impact van het gebruik van kleefmatten op de luchtreinheid met betrekking tot deeltjes en de deeltjesdepositiesnelheid in een operationele, industriële cleanroom. In industriële toepassingen is alleen de verwijdering van deeltjes belangrijk.
In een cleanroom voor de assemblage van apparatuur voor halfgeleider- en micro-elektronica processen van NTS is een vergelijking gemaakt tussen drie situaties: (1) geen kleefmat, (2) afpelmat en (3) Dycem mat vóór de ingang van de
Door: Koos Agricola, Brookhuis Applied Data Intelligence & Olof Teulings, NTS
cleanroom. De impact op luchtreinheid en deeltjesdepositie is gemonitord. Voor dit onderzoek heeft NTS een cleanroom, Dycem een polymere mat en Brookhuis Applied Data Intelligence meetapparatuur beschikbaar gesteld.
Hal (~ISO 9) Kleedsluis (ISO 8)
• Schoenen uit
• Haarnet op
• Baardnet i.v.t.
• Coverall aan
• CLR Schoenen
• Handschoenen
Cleanroom (ISO 7)
Voor het onderzoek is een ISO 7 productie cleanroom bij NTS geselecteerd. In deze cleanroom wordt procesapparatuur voor de halfgeleiderindustrie geassembleerd. In dagdienst werken dagelijks ongeveer 12 monteurs en soms proces- of kwaliteitstechnici in de cleanroom. Elke avond wordt de cleanroom door één persoon schoongemaakt. Het gemiddelde aantal binnenkomsten is 66 per dag. Personeel komt en gaat op willekeurige tijden in en uit de cleanroom, maar koffie-, lunch- en theepauzes zijn herkenbaar. Bij de ingang van de personensluis ligt een afpelbare kleefmat. De cleanroom kleding bestaat uit een haarnetje, eventueel baardnetje, overall, schoenen en handschoenen. Er zijn twee overstapbanken. De eerste wordt gebruikt om straatschoenen uit te trekken en de tweede om cleanroomschoenen aan te trekken (zie figuur 1). Een real-time onderzoek is lastig uit te voeren omdat de in- en uitgang en het gedrag van mensen niet constant en
moeilijk te reguleren zijn. Met een personenteller en toegangskaartlezer is getracht het aantal keren dat iemand de cleanroom binnengaat te bepalen. In het ingangsgebied van de cleanroom is elke vijf minuten de luchtreinheid op ongeveer 0,4 m boven de vloer gemeten met een 1 cfm lichtverstrooiing deeltjesteller Solair 3100 (bemonsteringstijd 1 minuut en monstervolume 28,3 liter/min). Op dezelfde locatie is de deeltjesdepositiesnelheid gemeten voor deeltjes > 15 µm met een realtime deeltjesdepositiemonitor APMON 2 (bemonsteringstijd 4 minuten en meetoppervlak 50 cm2).
Eén keer per dag is de oppervlaktereinheid van fluorescerende deeltjes > 20 µm gemeten met een oppervlaktereinheidmonitor SUMON (meetoppervlak 10 cm2). Oppervlaktereinheid verandert gedurende een dag door gebruik en dagelijkse schoonmaak. Helaas heeft deze laatstgenoemde oppervlaktereinheid geen bruikbare resultaten opgeleverd door het vrij hoge aantal vezels. Deze resultaten zijn daarom niet verder meegenomen in het onderzoek. De gemeten oppervlaktereinheidsniveaus lagen tussen SCP 6 tot 7 (zie [3]).




Het onderzoek is verdeeld over drie periodes van een week: (1) geen kleefmat, (2) een afpelmat (0,7 m2) die 2 keer per dag wordt ververst en (3) een Dycem polymere mat (1,5 m2) die volgens het reinigingsprogramma in de avond van elke werkdag wordt schoongemaakt (afbeelding 1).
Luchtreinheid
OPPERVLAKTEREINHEID VERANDERT
Deeltjes in cleanroomlucht bestaan uit zwevende en vallende deeltjes. De cleanroominstallatie verwijderd de zwevende deeltjes. Naarmate deeltjes groter (meestal ≥ 25 µm) en zwaarder zijn, wordt het steeds moeilijker deze met lucht te verwijderen. De deeltjes die niet verwijderd worden (vallende deeltjes) komen op de diverse oppervlakken terecht en moeten via reiniging verwijderd worden.
Hoe effectief de zwevende deeltjes worden verwijderd wordt bepaald door het aantal luchtwisselingen en de ventilatieefficiëntie. Daarnaast is de effectiviteit van het verwijderen van de vallende deeltjes afhankelijk van het schoonmaakprogramma van de omgeving, werkplek en product.
Het aantal zwevende deeltjes wordt gebruikt voor het bepalen van de lucht-
reinheid en cleanroom klasse. Dit gebeurt met een lichtverstrooiing luchtdeeltjesteller. Deze deeltjesteller is maar beperkt in staat om vallende deeltjes te meten vanwege hun geringe aantal en omdat ze aan de wanden van de bemonsteringslang kunnen blijven hangen. Voor de luchtreinheid met betrekking tot vallende deeltjes wordt de deeltjesdepositiesnelheid gebruikt.
De deeltjesdepositiesnelheid wordt bepaald door de lokale generatie van deeltjes en de verwijderingsefficiëntie van de cleanroominstallatie. De lokale generatie wordt bepaald door de manier waarop de cleanroom wordt gebruikt. Belangrijk zijn de procedures (afgeleid van de operationele beheersingsprogramma's) voor het naar binnen en buiten gaan van personeel en naar binnen en buiten brengen van goederen en de verwijdering van oppervlaktedeeltjes door reiniging.
De deeltjesdepositiesnelheid (zie [4]) is afhankelijk van de deeltjesgrootte D en wordt uitgedrukt voor verschillende deeltjesgroottes als:
RD is het cumulatieve aantal deeltjes ≥ D µm per m2 per uur
Bijvoorbeeld R 50 is het aantal deeltjes ≥ 50 µm per m2•uur
De deeltjesgrootte D wordt bepaald door de diameter van de kleinste cirkel rondom het silhouet (of de lengte) van een deeltje dat onder een microscoop wordt bekeken. R D is afhankelijk van de lokale luchtreinheid:
R D = concentratie van deeltjes ≥ D µm per m3 x cumulatieve depositiesnelheid in m/uur
Bijvoorbeeld is R 50 het aantal deeltjes ≥ 50 µm per m3 x ~470 m/uur.
De deeltjesdepositiesnelheid kan worden bepaald door de toename van de oppervlakteconcentratie op een testoppervlak ΔCs te meten voor en na blootstelling:
R D =(ΔCsD)/T
waarbij T de blootstellingstijd in uren is.
De deeltjesdepositiesnelheid kan ook worden uitgedrukt zonder een specifieke deeltjesgrootte D als een deeltjesdepositiesnelheidsniveau L. L is het equivalente aantal deeltjes ≥ 10 µm per m2•uur.
L wordt bepaald door het maximale product van deeltjesdepositiesnelheid R D en deeltjesgrootte D van de verschillende groottes die op een vergelijkbare manier worden geteld als het oppervlaktereinheidsniveau [3], in het equivalente aantal deeltjes ≥ 10 µm.
L = maximum ( RD • D 10 )
Met D: ≥ 5 µm tot ≥ 500 µm
Vaak wordt bij een goede cleanroominstallatie en cleanroomkleding de deeltjesdepositiesnelheid niveau L bepaald door de deeltjes > 100 µm, omdat deze deeltjes alleen door reiniging kunnen worden verwijderd.
Deeltjestransport vanaf de vloer Tijdens het passeren van de personensluis en het aantrekken van cleanroomkleding wordt de omgeving gecontamineerd door de emissie en verspreiding van deeltjes door een persoon. Er wordt aangenomen dat het aantal deeltjes omgekeerd evenredig is aan de deeltjesgrootte. Dit is niet waar voor deeltjes ≥ 200 µm wanneer er relatief veel vezels zijn. Deeltjes die niet door de luchtstroom worden verwijderd, zullen zich op alle oppervlakken neerslaan. Oppervlaktedeeltjes kunnen onder invloed van externe krachten opnieuw in de lucht terechtkomen en zich elders neerslaan. De verwachte herintreding zal in de orde van 0,01% van de oppervlaktedeeltjes ≥ 10 μm zijn en kan toenemen met de deeltjesgrootte [5]
Schoenen of overtreklaarzen in cleanrooms zullen ook een fractie in de orde van 10% van de oppervlaktedeeltjes (contactoverdracht coëfficiënt tussen 0,02 en 0,2) oppikken en deze naar de cleanroom transporteren. De deeltjes die van buitenaf naar de personensluis en van de personensluis naar de cleanroom worden getransporteerd, hebben invloed op de luchtreinheid en de deeltjesdepositiessnelheid in de cleanroom. Deze oppervlakteoverdracht kan worden verminderd door het gebruik van kleefmatten.
Een kleefmat verwijdert deeltjes van schoenoppervlakken. Een afpelmat gebruikt een lijmlaag om deeltjes te verzamelen die in de lijmlaag worden gedrukt. Een polymere Dycem mat heeft een flexibel bovenoppervlak dat een optimaal oppervlaktecontact creëert tussen deeltje
en mat. Omdat het contactoppervlak van een deeltje met het matoppervlak groter zal zijn dan het contactoppervlak met het schoenoppervlak, zullen de deeltjes aan het matoppervlak hechten en door de mat worden verwijderd. Dit principe is ook toegepast in Océ elektrofotografische kopieerapparaten en printers om 10 µm tonerdeeltjes van een fotogeleider over te brengen naar een substraat (papier) oppervlak met een zeer hoge efficiëntie [6]
De gegevens worden verzameld over drie periodes van één werkweek. In de week van 11 tot 15 maart 2024 is de Dycem kleefmat gelegd. De drie periodes zijn:
1. 26 februari tot 1 maart 2024, geen kleefmat;
2. 4 maart tot 8 maart 2024, afpelmat achter 2e overstapbank;
3. 18 maart tot 22 maart 2024, Dycem mat achter 2e overstapbank.
De gemiddelde luchtreinheid in de personensluis is gedurende de eerste twee dagen gemeten en deze was 19.000 deeltjes ≥ 0,5 µm per m3 en 2.880 deeltjes ≥ 5 µm per m3. Alle andere dagen wordt de luchtreinheid gemeten in de cleanroom.
In het geval dat er geen mensen in de cleanroom zijn (tijdens pauzes wanneer de cleanroom in rust is) werden er geen deeltjes ≥ 0,5 µm geteld. De luchtreinheidsgegevens in de cleanroom worden alleen meegeteld wanneer het aantal deeltjes ≥ 0,5 µm groter is dan 0. De gemiddelde gegevens worden genormaliseerd naar het aantal cleanroom-ingangen (gemid-
delde concentratie vermenigvuldigd met gemiddeld aantal betredingen/betredingen per dag). De verkregen luchtreinheidsgegevens voor deeltjes ≥ 0,5 µm en deeltjes ≥ 5 µm per m3 worden weergegeven in tabel 1. Per dag wordt het aantal betredingen gegeven. Alle gemeten deeltjesgrootteverdeling zijn te zien in figuur 2.
Voor deeltjes ≥ 5 µm is de concentratie onder de ISO 7 lijn te zien. Voor kleinere deeltjes valt de concentratie binnen ISO 6-verdeling. Het verschil tussen geen mat en mat is duidelijk te zien. Het verschil tussen afpelmat en Dycem mat is kleiner. De Dycem mat geeft de laagste concentraties in de lucht. Interessant is dat ook de concentratie van deeltjes ≥ 0,3 µm en ≥ 0,5 µm lager zijn met een mat.
Deeltjesdepositiessnelheid
Wanneer er geen activiteit is, is er geen deeltjesdepositie. Daarom worden de deeltjesdepositiessnelheidsgegevens verzameld in het geval dat er deeltjesdepositie is (R15 > 0).
In tabel 2 worden de resultaten voor R 50, R100 en het deeltjesdepositiesniveau weergegeven. De gemiddelde gegevens zijn genormaliseerd naar het aantal cleanroom-ingangen (gemiddelde concentratie vermenigvuldigd met gemiddelde betredingen/betredingen per dag).
Het is te zien dat het depositiesnelheidsniveau van deeltjes wordt bepaald door de depositie van grote deeltjes ≥ 500 µm. Veel van deze deeltjes hebben een vezelachtige vorm. Er is een grote verbetering te zien tussen geen mat en een kleverige mat. De Dycem mat levert de beste prestaties, vooral voor grotere deeltjes.
De waargenomen depositiesnelheid van deeltjes is relatief hoger voor deeltjes > 100 µm. De verdeling van de depositiesnelheid van deeltjes voor verschillende deeltjesgroottes geeft informatie over de effectiviteit van maatregelen voor
Datum Kleefmat Aantal betredingen
1: Dagelijkse gemiddelde concentratie van zwevende deeltjes C0,5 en C 5
Deeltjesconcentratie in de lucht
Geen kleefmat
Afpelmat
Dycem mat
ISO 7
ISO 6
Deeltjesdepositiesnelheid
Deeltjesdepositiesnelheid
Tabel 2: Dagelijkse gemiddelde deeltjesdepositiessnelheid R 50 en R100 en het deeltjesdepositiessnelheidsniveau L.
besmettingscontrole. Van 10 tot 40 µm is de impact van de cleanroominstallatie te zien. Van 50 tot 100 µm is de impact van de cleanroomkleding en de wisselprocedure te zien. Voor deeltjes > 100 µm is de effectiviteit van het reinigingsprogramma
te zien. Bij de ingang kunnen kleverige matten de overdracht van buiten naar de cleanroom verminderen. De impact op de deeltjesdepositiesnelheid is te zien in figuur 3.
Figuur 3: Deeltjesgrootteverdeling per type mat en het bijbehorende deeltjesdepositiesnelheidsniveau.
In plaats van een efficiëntiestudie van kleefmatten is de invloed van hun gebruik in een operationele cleanroom voor de assemblage van halfgeleiderproductieapparatuur onderzocht. In zo'n echte situatie kunnen veel parameters niet worden beheerst. Het gedrag van personeel, dat met een flexibel schema werkt, is moeilijk te volgen. De impact van de binnenkomst van personeel is gemonitord bij het ingangsgebied van de cleanroom achter de toegangsdeur van de personensluis. De verzamelde gegevens tonen een positieve impact van het gebruik van kleefmatten op zowel luchtreinheid als deeltjesdepositie. Dycem polymere mat gaf een beter resultaat dan de afpelmat.
[1] Sandle T (2023) Reducing the fungal footwear risk: Evaluating polymeric antimicrobial flooring for cleanroom entry. DOI: 10.13140/RG.2.2.12757.19680 Research Gate
[2] Prout G (2013), The nature and environmental impact of control of floor level contamination. Clean Air and Containment Review 16 p8 – 13
ANALYSE VAN VERZAMELDE GEGEVENS
Om de impact van kleefmatten op de reinheidsniveaus van de cleanroom te evalueren, zijn de gemiddelde gegevens per periode verzameld in tabel 3. Het resultaat van elke periode wordt gegeven voor luchtreinheid en deeltjesdepositiesnelheid.
De verbetering is berekend volgens: 1niveau mat /niveau zonder mat uitgedrukt in percentages.
Zowel het luchtreinheidsniveau als het deeltjesdepositiessnelheid niveau laten een grote verbetering zien bij het gebruik
van kleefmatten. De resultaten van de Dycem polymere matten waren beter dan die van de afpelmatten.
Waarschijnlijk was het verschil in verbetering van het niveau van de deeltjesdepositiessnelheid tussen de afpelmat en de Dycem mat klein vanwege het verschil in reinigingsfrequentie. De afpelmat werd twee keer per dag ververst en de polymere mat werd één keer per dag gereinigd met een vlakmop. De aanbevolen reinigingsrichtlijnen (trekker) werden niet volledig ondersteund en kunnen een factor zijn in de bevindingen.
[3] ISO 14644-9 Cleanroom and associated controlled environment. Assessment of surface cleanliness for particle concentration. International Organisation for Standardization, Geneva
[4] ISO 14644-17 Cleanroom and associated controlled environment. Particle deposition rate applications, International Organisation for Standardization, Geneva
[5] Agricola K (2022), The role of surface cleanliness in contamination control. Proc. SPIE 12224, Space Systems Contamination: Prediction, Control, and Performance 2022, doi: 10.1117/12.2632673
[6] Logister J (2024), Niet 100%, wel erg succesvol. The development of the Océ 1900 copier through R&D glasses. ISBN: 97890828791254


In een eerder artikel (Contamination Control Magazine september 2024) over dit onderwerp is uitgebreid ingegaan op de problematiek van het meten van deeltjes verontreiniging aan de binnenkant van een product. De gangbare meettechnieken waarmee je deeltjesverontreinigingen op oppervlakken kunt meten schieten hierbij tekort, omdat de oppervlakten aan de binnenkant van het product niet toegankelijk zijn voor deze technieken. Toch is het van cruciaal belang dat ook dit soort producten gekwalificeerd kunnen worden op de mate van reinheid met betrekking tot deeltjes. Denk hierbij aan onderdelen van een gasverzorgingssysteem waarbij mogelijk aanwezige (airborne) deeltjes vervuiling door de gasstroom meegevoerd kan worden naar plaatsen waar ze ongewenst zijn of zelfs grote schade kunnen aanrichten.
Naar aanleiding van de behoefte vanuit de hightech maakindustrie om de mate van deeltjesreinheid aan de binnenkant van producten te kunnen meten, is er vanuit deze industrie zelf een meetmethode ontwikkeld. Hierbij worden eventueel aanwezige deeltjes door een gasspoeling uit het product gedreven, waarna ze geteld kunnen worden. In deel 1 van dit artikel is beschreven hoe deze meetmethode in het algemeen is opgebouwd en wordt uitgevoerd. Dit artikel focust zich voornamelijk op meetstrategieën, data-interpretatie en de valkuilen die opdoemen wanneer je een dergelijk meting uitvoert.
De commercieel verkrijgbare airborne particle counters, die worden gebruikt voor de classificatie van deeltjes verontreiniging in cleanrooms, kunnen ook gebruikt worden voor de validatie van deeltjesafgifte van producten. In deel 1 van dit tweeluik is de algemene werking van deze instrumenten uitgelegd. Er zijn verschillende instrumentleveranciers die deze apparaten op de markt brengen en van allemaal zijn de meetprotocollen gebaseerd op de ISO 14644-1 (2015) norm [1], die het kwalificeren van deeltjes in cleanroom lucht beschrijft. Cleanroom lucht is echter beduidend anders dan een gas dat onder een hoge flow door een product wordt gespoeld. Cleanroom lucht is over het algemeen een (in meer of mindere mate) laminaire gasstroom. Het aantal deeltje per kubieke meter lucht is, afhankelijk van de ruimteclassificatie, toch nog vrij hoog. Zo mag een ruimte met een ISO klasse 5 specificatie nog steeds 100.000 deeltjes/ m3 van 0.1 µm of groter bevatten, waarvan 832 deeltjes/m3 met een diameter van 1 µm of groter. Voor een productkwalificatie gelden vaak veel strengere eisen. Daarbij wordt de lucht met een hoge flow en vanwege de interne diameter van het product dus ook met een hoge lineaire gassnelheid (turbulentie) door het product gespoeld. Ook is het zo dat de testflow voor de verschillende onderdelen kan variëren en vrijwel nooit gelijk is aan de intake flow van de particle counter. Flows kunnen variëren van 0,1 tot 500 Nlm (en zelfs hoger). Om de
commerciële particle counters te kunnen gebruiken voor de complete range zijn een aantal meetstrategieën ontwikkeld die zijn terug te brengen tot vier verschillende situaties:
1. Geen onderdeel flow gedefinieerd;
2. Flow door onderdeel < intake flow particle counter;
3. Flow door onderdeel = intake flow particle counter;
4. Flow door onderdeel > intake flow particle counter.
In geval van situatie 1) en 2) wordt er vaak voor gekozen om de flow door het onderdeel te verhogen en daarmee situatie 3) te verkrijgen. Een hogere flow ‘slaat’ meer particles los en als het onderdeel bij een hogere flow aan de specificatie voldoet, zal hij zeker ook bij een lagere specificatie voldoen. Dat zal ook vrijwel altijd een schoner eindproduct opleveren. Het is mogelijk om hierbij gebruik te maken van de eigen pomp van de particle counter.
De uitgang van het product wordt dan direct op de ingang van de particle counter aangesloten. Met een ‘zero filter’ op de ingang van het product trekt de particle counter dan particle-vrije cleanroom lucht door het onderdeel. Elk deeltje dat geteld wordt is dan afkomstig van het product. Deze strategie werkt niet als de pomp onvoldoende vermogen heeft om de weerstand van het onderdeel te overwinnen of als het niet is toegestaan om de testflow te verhogen. Dan wordt ervoor gekozen voor situatie 3) met de opstelling die in het eerste deel van dit tweeluik is
besproken (gasbron->MFC->filter->onderdeel->counter) en schematisch weergegeven in Figuur 1.
Via een T-stuk tussen de particle counter en het onderdeel wordt de hoeveelheid benodigde lucht voor particle counter aangevuld door de eigen pomp. Belangrijk is hierbij op te merken dat dit een verdunning van het meetgas oplevert. De benodigde hoeveelheid gas door het onderdeel om de gewenste specificatie te halen moet hiervoor worden gecorrigeerd. Dit betekent altijd een toename van de vereiste meettijd. Als de test flow gelijk is aan de intake flow van de particle counter wordt er vanwege pragmatische redenen altijd een iets hogere flow (35 Nlm) gekozen. Dit omdat het vrijwel onmogelijk is om de testflow exact gelijk aan de intake flow van de particle counter
Figuur 1: Schematische weergave situatie 3).
in te stellen. De overmaat flow wordt via een T-stuk afgeblazen. Wat ook een bescherming geeft tegen terug-diffusie van cleanroom lucht.
Deze strategie wordt ook toegepast in situatie 4) (zie figuur 2 voor een schematische weergave). Vanaf een bepaald moment is het echter niet meer mogelijk om de overflow met een eenvoudig T-stuk af te blazen. Bij een te hoge flow gaat het venturi-effect, veroorzaakt door het T-stuk, een dusdanig grote rol spelen dat dit een negatief effect geeft op de stabiliteit van de intake flow van de particle counter. Dat effect wordt zichtbaar als een toename van het aantal deeltjes met de kleinste afmetingen. Dat zijn geen echte deeltjes, maar sensorruis veroorzaakt door de instabiele flow in de meetcel. De flow waarbij dit effect gaat optreden ligt ergens rond de 100Nlm. Dat is afhankelijk van het type counter dat gebruikt wordt en de stabiliteit van de laser/sensor combinatie.
Bij testflows hoger dan 100 Nln kan dus niet meer worden volstaan met een eenvoudig T-stuk voor het afblazen van het overtollige spoelgas. Daarbij gaat ook de homogeniteit van het gas een steeds grotere rol spelen. Bij een flow tot 100 Nlm is de deelflow die de particle coun-
VENTURI-EFFECT, VEROORZAAKT
ter wordt ingetrokken, iets meer dan een kwart van het totaal. Om toch een juiste concentratiemeting te doen moeten de deeltjes homogeen over het gas verdeeld zijn. Vanwege de ontstane turbulentie is dit meestal ook wel het geval. Bij flows boven de 100 Nl wordt deze verhouding steeds lager. Om dit te voorkomen is er een manifold ontwikkeld met een soort tweetraps benadering. In het manifold neemt de turbulentie eerst toe waardoor er een betere menging optreedt. Vervolgens wordt deze turbulentie teruggebracht en wordt de flow in twee delen gesplitst. De kleinste deelflow wordt naar de particle counter geleidt om volgens via de standaard manier te worden gemeten. De interne configuratie van dit manifold is met behulp van CFD (Computational Fluid Dynamics) gemodelleerd en getest. Het uiteindelijke ontwerp voldoet aan de verwachtingen en kan, met enige aanpassingen, over een brede flow range tot zeker 500 Nlm worden toegepast.
Het ontwerp van deze ‘hoge flow’ toepassing’ bracht direct een andere beperking aan het licht. Een echte validatie met een ‘golden standard’ is niet mogelijk. Er bestaan geen gecertificeerde referentie -cilinders met een bekende concentratie aan deeltjes, zoals er bijvoor-
beeld wel zijn voor gasvormige componenten. Overigens geldt dit ook voor de lage flowmetingen. Het is vrij ingewikkeld en kostbaar om een gasstroom te creëren met een constante en bekende concentratie aan deeltjes. Voor het gebruik van de particle counters zoals in deze artikelen beschreven, zou deze concentratie ook nog eens aan de lage kant moeten zijn. Alleen dan wordt kalibratie en validatie verkregen op het niveau dat in de hightech maakindustrie gevraagd wordt.
Dit soort installaties bestaan wel en zijn vrijwel alleen maar in gebruik bij producenten van particle counters. Deze worden voornamelijk gebruikt om de ‘primaire’ counters mee te kalibreren. Vervolgens worden deze counters gebruikt als referentie voor de vele counters in het veld. Voor een laboratorium dat routinematige kwaliteitscontroles uitvoert, zou dit een veel te dure investering zijn. Standaard worden de counters minimaal één keer per jaar gekalibreerd door de leverancier van de counter. Hierbij gaat het voornamelijk om de juiste afstelling van de deeltjesgrootte die met deze toestellen gemeten kunnen worden. Onderhoud hebben de meeste toestellen ook slechts één keer per jaar nodig. Ze zijn ontworpen om gedurende langere tijd 24/7 te blijven draaien. Daarbij moet wel in de gaten gehouden worden
dat de lucht, die voor dit type metingen gebruikt wordt, over het algemeen vrij droog is. Dat veroorzaakt meer schade aan de schoepen van de pomp van de particle counters dan wanneer er cleanroom lucht gemeten wordt. Het vocht in de lucht fungeert als een smeermiddel en bij langdurig gebruik van te droge lucht moet de pomp wat vaker vervangen worden.
Wanneer je eenmaal de beschikking hebt over een gekalibreerde particle counter en de juiste meetopstelling, ben je in staat data te genereren. Om daar een juiste conclusie uit te trekken zul je de data moeten interpreteren en verwerken tot een meetresultaat waarmee je de beslissing kunt nemen of het onderdeel voldoet aan de gestelde specificatie. Voor cleanroom lucht is dit vrij recht-toe-rechtaan en geeft de ISO14644 norm aan hoe je dit moet doen. Voor producten die aan een gasspoeling worden onderworpen, waarbij geteld wordt hoeveel deeltjes met het spoelgas mee komen, ligt dit iets ingewikkelder. Voor producten met de strengste reinheideisen is het aantal deeltjes dat tijdens de testperiode acceptabel is, vaak minder dan 10 deeltjes (> 0,1 µm)/ m3 spoelgas. Wanneer je dit zou vergelijken met standaard cleanroom lucht zou dit overeenkomen met ISO Klasse 1. In de praktijk blijkt ook dat deze producten vaak zo schoon zijn en dat er tijdens de testperiode nauwelijks deeltjes vrijkomen. Af en toe wordt er een deeltje gedetecteerd. Uit een literatuurstudie naar de fysica van deeltjesafgifte van oppervlakken is gebleken dat er geen eenvoudige aanpassing van het ISO-protocol is voor gasgespoelde onderdelen. Oorzaak hiervan zijn de speciale kenmerken van oppervlaktedeeltjesafgifte, zoals het voorkomen van deeltjesclusters (bursts). Mede om deze reden is het beter om de reinheidskwalificatie uit te drukken in het aantal deeltjes gedetecteerd per kubieke meter spoelgas in plaats van de voor cleanrooms gebruikelijke ISO-classificatie.
De ISO14644-1 norm is echter nog wel bepalend voor de bijbehorende meetstrategieën. Met name de testduur om tot een juiste uitspraak te komen of een testobject aan de gestelde specificatie voldoet, wordt bepaald door het maximaal toelaatbare aantal deeltjes/m3. Dit heeft alles te maken met telstatistiek en staat uitgebreid beschreven in deel 1 van deze norm. Om te beoordelen of een bepaald onderdeel/module voldoet aan een bepaalde classificatie moet de meetfout van het experiment in acht genomen worden. Een meetfout kan leiden tot verkeerde beslissingen. We onderscheiden twee verschillende soorten verkeerde beslissingen: foutieve afwijzing van een onderdeel dat daadwerkelijk schoon (α-fout) en foutieve acceptatie van een onderdeel dat daadwerkelijk vuil is (β -fout).
Voorbeeld
Om te illustreren wat dit inhoudt, gaan we terug naar het ISO-klasse 1-voorbeeld. De maximaal toegestane concentratie is 10 deeltjes/m3 met een minimaal bemonsterd volume van 2 m3, dus een totaal aantal van 20 deeltjes. Laten we aannemen dat de fout op de meting volledig wordt bepaald door telstatistieken
(Poisson-verdeling). Door te vergelijken met tabellen voor de Poisson-verdeling [2] , kunnen we concluderen dat de α-fout 0,05 of minder wordt wanneer het totale aantal 29,06 of groter is. Omgekeerd wordt de β-fout 0,05 of minder wanneer het totale aantal 14,07 of minder is. Het is belangrijk om onderscheid te maken tussen de onbekende werkelijke concentratie “M” en het aantal van een beperkt monster lucht. De beslissing goed- of afkeur is gebaseerd op het meten van een beperkt volume lucht, namelijk de 2 m3 die in de ISO-norm staat. Merk op dat de beslissingsregel “≤ 20” slechts gedeeltelijke informatie geeft over de werkelijke reinheid. In feite heeft een cleanroom met exact M = 20 deeltjes per 2 m3 een kans van 55,9% dat een monster van 2 m3 een aantal van ≤ 20 heeft en daarom een kans van 44,1% om (ten onrechte) te worden afgekeurd.
Bovenstaande toont aan dat (voor cleanroom lucht!), als er maar weinig deeltje voorkomen, de meetfout relatief groot is.
Het feit dat de spoelflow vaak groter is dan de ‘intake flow’ van de particle counter maakt bovenstaande waarschijnlijkheidsberekening er niet eenvoudiger op. Bij een hogere spoelflow zal er slechts een gedeelte in de particle counter worden getrokken om de daar aanwezige deeltjes te kunnen tellen. Als de deeltje homogeen over de spoelflow verdeeld zijn is dit probleem minder significant. In de praktijk hebben we echter meestal te maken met ‘deeltjes uitbarstingen’ en de kans dat deze deeltjes zich evenredig over de twee ‘deel-flows’ verdelen is onvoorspelbaar. EEN
Zoals ook al in deel 1 van dit artikel is gezegd, zijn er nogal wat onzekerheden aan deze manier van het kwalificeren van onderdelen op de afgifte van deeltjes. Omdat er geen alternatieven voorhanden zijn waarmee dit soort metingen op grote schaal en tegen relatief lage kosten uitgevoerd kunnen worden, is gekozen voor een pragmatische benadering. Ondanks de beperkingen en de meetonzekerheden op extreem lage niveaus is er bij het opstellen van de meetprotocollen toch gebruikgemaakt van de procedures zoals genoemd in de ISO 14644-1 norm. Zo is het voorgeschreven om voor een classificatie van maximaal 10 deeltjes (> 0,1 µm)/m3 spoelgas, minimaal 2 m3 spoelgas door de particle counter te leiden (ongeacht de spoelflow waarmee het item getest wordt). Dit betekent bij een intake flow van 28,3 L/min, zoals de meeste particle counters gebruiken, dat een meting minimaal 70 minuten duurt. Voor een meting met een classificatie van maximaal 100 deeltjes (> 0,1 µm)/m3 spoelgas komt dit neer op 7 minuten meettijd. In de praktijk wordt echter altijd een meettijd van minimaal 15 minuten aangehouden. Ook voor minder strenge specificaties. Dit om te voorkomen dat eventuele deeltjes die gegenereerd worden tijdens het aansluiten van de te testen onderdelen bepalend zijn voor de uiteindelijke kwalificatie. Het aansluiten van onderdelen gebeurt vaak met behulp van ‘press-fit’ of ‘face seal’ koppelingen. Dit zorgt altijd voor frictie met de kans dat er deeltjes vrijkomen. Door de meettijd wat te verhogen en bijv. de eerste 5 minuten niet in acht te nemen wordt voorkomen dat een onderdeel wordt afgekeurd op het vrijkomen van deeltjes die niet van het onderdeel zelf afkomen. Voor specificaties die ergens tussen de standaard specificatie van de ISO14644 norm in liggen, biedt de norm de mogelijkheid om de vereiste meettijd te berekenen.
In de praktijk komt het vaak voor dat, tijdens een meting met een langere meettijd, door het ontstaan van een zogenaamde ‘particle burst’, het totaal aantal aanvaardbare deeltjes volgens de specificatie van dit specifieke onderdeel in een split second wordt overschreden. Dat zorgt dus voor afkeur. Vaak blijkt dit pas na afloop van de meting en evaluatie van de data. De meest voorkomende strategie is dan om de meting te herhalen. Immers, de meting zelf is eigenlijk ook een spoelproces waarbij het onderdeel onder test tegelijkertijd gereinigd wordt. Handig is in dit geval om via software ervoor te zorgen dat je de meting real-time kunt volgen. De meting kan dan doorlopen terwijl je de voorgaande periode analyseert. Mocht het om een afkeur gaan, dan win je hiermee tijd. Er bestaat de mogelijkheid om de data-analyse te automatiseren, waardoor je van minuut tot minuut een voortschrijdend inzicht krijgt over een vooraf ingestelde meetperiode. Als de specificatie is gehaald dan kan de meting automatisch worden beëindigd, maar blijft doorlopen zolang dit nog niet het geval is. Deze software is echter niet commercieel verkrijgbaar en zal ‘in-huis’ geschreven moeten worden waarbij hulp van de counterleverancier waarschijnlijk noodzakelijk is om de juiste informatie real-time uit de counter te krijgen.
Bij het ontstaan van meerdere particle bursts in korte tijd, of een continue afgifte van deeltjes, is het aan te raden om het onderdeel, voordat de herhaalmeting wordt uitgevoerd, eerst te spoelen met schoon gas (=reinigen) met een flow die beduidend hoger is dan de voorgeschreven meetflow. Bij extreme vervuiling is het aan te raden om de onderdelen via de klassieke ‘natte reiniging’ nog eens extra schoon te laten maken.
De ISO14644 norm beschrijft een andere mogelijkheid om de soms langdurige meettijden te verkorten. Hiervoor wordt gebruik gemaakt van de zogenaamde ‘sequential sampling’ techniek [1]. Sequential sampling’ is een type acceptatiebemonstering [3]. Dit bemonsteringsplan heeft als voordeel dat het eerdere beslissingen mogelijk maakt en dus de meettijd verkort, zonder de beslissingskwaliteit te verslechteren. In de eenvoudigste vorm is acceptatiebemonstering een procedure voor het accepteren of afwijzen van een batch of lot geproduceerde artikelen. Er wordt een monster genomen uit een grote batch en de artikelen uit het monster worden geïnspecteerd op defecten. Er is een beslissingsregel van kracht, bijvoorbeeld dat er een vaste steekproefomvang wordt genomen en de batch wordt afgewezen als het aantal defecten boven een voorgeschreven limiet ligt (en anders wordt geaccepteerd). Bij sequentiële bemonstering is de steekproefomvang of bemonsteringstijd niet langer vast. Figuur 3 illustreert de werking van sequentiële bemonstering toegespitst op de ISO14644-1 norm voor cleanroom lucht [1]. De horizontale as is het meetnummer, wat tijd of volume lucht kan zijn (in de praktijk is dit meestal een meettijd van 1 minuut). De verticale as toont het cumulatieve deeltjesaantal tot het gegeven punt. Voorbeelden 1 en 2 in de grafiek tonen voorbeelden van een cumulatief tel pad. De rode en blauwe lijnen geven de
beslissing aan om het onderdeel te weigeren of te accepteren:
• Bovenste hellende lijn “rej”: keur het onderdeel af als de telling hoger wordt.
• Onderste hellende lijn “acc”: accepteer het onderdeel als de telling lager wordt dan deze lijn.
• Let op: voor de eerste 4 meetinter vallen (grafiek) kan dit niet kan gebeuren, omdat de lijn onder count=0 ligt.
• Groene horizontale lijn “rej20”: het onderdeel wordt geweigerd als de telling groter is dan 20 (ISO-optelling).
• Na een voorgeschreven aantal metingen (twintig in het voorbeeld) wordt een beslissing genomen; accepteer als count≤20, anders weiger (ISOoptelling)’.
In de grafiek wordt voorbeeld 1 (in oranje) geaccepteerd na negen meetintervallen omdat het de onderste hellende lijn snijdt. Voorbeeld 2 wordt afgewezen wanneer het de rode lijn snijdt bij meting #13. In de basis maakt de sequential sampling techniek dus gebruik van een aantal eerder uitgevoerde metingen om te voorspellen wat de uiteindelijke uitkomst zal zijn na afloop van de gehele meettijd. De betrouwbaarheid van die voorspelling is gebaseerd op de posities van beide beslislijnen.
De sequentiële bemonsteringstechniek zoals in de ISO-norm beschreven is echter toegepast op de meting van deeltjesconcentraties in cleanroom lucht. Daarbij wordt aangenomen dat de deeltjesconcentratie in de cleanroom min of meer constant is in de tijd. Bij het kwalificeren van de deeltjesreinheid van onderdelen/ modules door de deeltjesconcentratie in het spoelgas te meten is dat niet het geval. De beide beslislijnen zoals in de ISO-norm beschreven mogen dus niet zonder meer worden toegepast voor dit soort metingen omdat die geen rekening houden met het fenomeen van ‘particle bursts’.
Onderzoek [4] heeft aangetoond dat de sequential sampling techniek wel bruikbaar kan zijn en dat tijdsbesparingen tot een factor 2 mogelijk zijn. Daartoe is het noodzakelijk om een groot aantal standaardmetingen op een specifiek onderdeel uit te voeren. De daarmee verkregen data worden volgens in een rekenmodel gestopt waarmee de beslislijnen voor dit specifieke onderdeel kunnen worden berekend. Het is ook gebleken dat de beslislijnen van verschillende onderdelen, die evengoed wel vergelijkbaar zijn, nauwelijks van elkaar afwijken.
Uit bovenstaande overwegingen blijkt dus opnieuw dat het meten van de deeltjesconcentratie in cleanroom lucht niet zomaar één op één is te vergelijken met gasgespoelde onderdelen. Ook het feit dat er geen on-site kalibratie en/of validatie uitgevoerd kan worden, is voor de laboratoria die deze technieken toepassen een doorn in het oog. Dit druist in tegen het wetenschappelijk geweten en alles wat wij hebben geleerd op het gebied van analytische chemie. Maar zoals al eerder gezegd, er zijn geen alternatieven voorhanden om dit soort metingen snel en tegen lage kosten uit te voeren. De pragmatische benadering heeft zich in de afgelopen jaren bewezen en ook in de toekomst zullen dit soort metingen nodig blijven en toegepast worden om de reinheid van hightech maakonderdelen te kunnen blijven garanderen. De trend die daarbij nu al valt te zien, is dat er meer interesse komt in nog kleinere deeltjes. Recent zijn er al meetstrategieën ontwikkeld voor metingen van deeltjes met een diameter vanaf 10 nm. Hoewel de procedures redelijk overéén komen, zijn de eisen m.b.t. de reinheid van de onderdelen van de opstelling een stuk strenger. Voor het detecteren van de deeltjes is een ander type counter nodig die de mogelijkheid biedt deeltje te detecteren met een nog kleinere diameter. Hiervoor wordt over het algemeen een condensation particle counter gebruikt. Om meer inzicht te krijgen in de achtergronden van deze metingen, is echter nog heel wat aanvullend onderzoek noodzakelijk.
[1] ISO 14644-1, Cleanrooms and associated controlled environments-Part 1: Classification of air cleanliness (2015).
[2] A.J. Duncan, Quality Control and Industrial Statistics, Irwin, Homewood, IL, USA (1974).
[3] A. Wald, Sequential Analysis, Wiley, New York (1947).
[4] Intern onderzoeksverslag, company confidential, niet voor publicatie










STARTDATUM
14 OKTOBER 2025
Het belang van een schoon eindproduct of een schone productielijn neemt in steeds meer sectoren toe. Er geldt klein, kleiner, kleinst en schoon, schoner, schoonst. Of het nu de halfgeleiderindustrie, de life science industrie, de hightech productie-industrie of foodproductie industrie is, de reinheidseisen aan het product en proces nemen toe en worden strenger. Om hiervoor de juiste maatregelen te kunnen nemen en te komen tot een schoon eindproduct is brede kennis nodig van het vakgebied Contamination Control en Cleanliness. De nieuwe VCCN post-hbo opleiding Contamination Control & Cleanliness biedt deze kennis op een integrale wijze en geeft de benodigde vaardigheden voor ontwerpers, bouwers en beheerders van cleanrooms en schone productielijnen.
Na het volgen van de opleiding heb je inzicht in de verschillende contaminanten die de functionaliteit van producten of processen beïnvloeden. Je leert ook welke maatregelen nodig zijn en hoe je een cleanroom of een vergelijkbare beheersbare omgeving kunt opzetten. Met deze uitgebreide kennis ben je in staat om zelfstandig vragen van zowel interne als externe opdrachtgevers te analyseren. Door het zelf stellen van de juiste vragen kun je de behoeften verder verkennen. Dit leidt tot een programma van eisen waarin de reinheidseisen voor het product of proces worden gedefinieerd. Je kunt deze eisen vertalen naar de nodige maatregelen voor de realisatie en het gebruik van een controlled environment.
• De opleiding behandelt de verschillende aspecten in relatie tot een schoon eindproduct of proces.
• Product- en procesanalyse
• Vertalen reinheidseisen naar maatregelen
• Reiniging en desinfectie (productniveau)
• De controlled environment
• Cleanroom ontwerp en constructie


• HVAC
• Containment
• Cleanroom validatie en classificatie
• Cleanroom beheer
• Specifieke toepassingen
• Risico-analyse
Bovenstaande onderwerpen worden in een opleidingstraject van 15 dagen behandeld. Naast de contacttijd is er de nodige zelfstudie. De opleiding zal een post-hbo registratie krijgen bij Stichting phbo.
Een afgeronde hbo opleiding of relevante mbo opleiding met voldoende ervaring.




“Wat een geweldige dag was dit!” aldus dagvoorzitter Philip van Beek na afloop van de eerste Cleanliness Day die 11 maart 2025 plaats vond op de High Tech Campus in Eindhoven. “VCCN heeft met dit congres haar missie
Sharing the knowlegde echt eer aangedaan.” De Cleanliness Day bracht bijna 200 professionals, 22 bedrijven op de bedrijvenmarkt en een line-up van zeer interessante sprekers bijeen om de laatste ontwikkelingen en oplossingen op het gebied van productreinheid en contaminatiebeheersing te bespreken.
Overall conclusie van de lezingen was dat om het gewenste hoge niveau van productreinheid te bereiken, samenwerking en beheersing in de gehele productieketen noodzakelijk is.
Het belang van schone productiemethoden en schone ruimten blijft de komende jaren beslist toenemen. Zowel de openingslezing over Artifical Intelligence (AI) als de keynotelezing over de toekomst van de lithographie bevestigden dit.
Spreker Marijn Markus (foto 2) nam de zaal mee in de wereld van AI. De technologie achter de toenemende rekenkracht in de komende decennia. Markus liet zeer interessante voorbeelden zien van wat AI op dit moment al kan. Maar ook waar het vandaan komt en wat de ontwikkeling en innovatie stuwt. En dan zie je dat het ook een vorm van evolutie is, met name over de wijze hoe met data wordt omgegaan en wat er mee kan worden gedaan. En moeten we bang zijn voor AI? Toen Google in 1998 begon was dat een nieuwe manier van omgaan met data, en nu is het zelfs een werkwoord. Door de toenemende rekenkracht worden de AI-modellen beter en sneller waardoor meer zaken mogelijk zijn, denk hierbij aan generative AI of het herkennen van tumoren in een scan. Er zullen dan ook zeker revoluties t.a.v. werkmethoden en toepassingen komen waar we mee om moeten gaan.
De toenemende rekenkracht, nodig voor de ontwikkeling van AI, is de kern van de
keynote lezing van Marc Assinck van ASML (foto 3). Met een interessante blik op de toekomst van lithographie, de productie van microchips en de ontwikkelingen binnen ASML werd de zaal het laatste uur geboeid. Moore’s law stond hier centraal. Deze luidt dat het aantal transistors op een microchip elke 2 jaar verdubbelt en daarmee ook de rekenkracht vergroot. De toepassingen nemen daarmee ook toe. Op dit moment bevinden we ons in het tijdperk van AI en Smart mobilty. De ontwikkelingen bij ASML richten zich op het behoud van deze wetmatigheid. Assinck sprak de verwachting uit dat deze ontwikkeling nog zeker 20 jaar duurt.
SCHOON WERKEN
Bovenstaande ontwikkelingen zorgen voor steeds strengere eisen aan de gebruikte componenten en omgeving. Het kritieke proces heeft al plaats in vacuum en ook de ruimte waarin wordt gewerkt heeft hoge reinheidseisen. Dit geldt ook voor de componenten waaruit de machine is opgebouwd. Dit hele
DOOR DE TOENEMENDE

een dag die inspireert en u


de productie van een microchip.”
proces van halffabrikaat tot eindproduct vraagt om een integrale aanpak van reinheidseis tot maatregelen, afgestemd op de eisen van de OEM-onderneming en uit te voeren bij de assemblage en bij de n-trier bedrijven.
Koos Agricola (foto 4) maakte de toehoorders bewust van de noodzaak om eerst goed na te denken over de reinheidseisen, mogelijke contaminanten en blootstellingstijd van de kritieke oppervlakken voordat besloten wordt tot maatregelen. Vaak wordt te snel besloten tot een bepaalde klasse cleanroom terwijl dit wellicht niet nodig is. Of een verkeerde reinigingsmethode die niet toereikend is. Kortom, een pleidooi voor de juiste strategie voor productreinheid gedurende de gehele fabrikageketen inclusief verpakking en transport. Het door Agricola geschreven boek en VCCN richtlijn 12 (beiden verkrijgbaar bij VCCN) geven de theorie en handvatten om dit vorm te geven.
Frank van Otten (foto 5), Operation engineer parts precision and clean working bij Thermo Fisher, onderstreept het belang om de juiste ambitie te hebben t.a.v. productreinheid. Bij de fabricage van de elektronenmicroscoop zijn de reinheidseisen zeer streng en betreffen zowel chemische-, deeltjes-, oppervlakteen vochtverontreinigingen. Zeer kleine verontreinigingen hebben al grote gevol-
gen voor de goede werking van het apparaat. Deze eisen worden zowel intern als ook extern aan de toeleveranciers gesteld. Om dit te realiseren ondersteunt Thermo Fischer de first- en n-tiers bij dit proces en vooral ook bij de keuze van de reinigingsmethodieken voor de pre-cleaning, precision cleaning en de high purity cleaning. Het proces van High Purity Cleaning werd uitgebreid toegelicht.
CONTAMINATION CONTROL MANAGEMENT STRATEGY
Ook in de lezing van Richard Bruls (foto 6) van ASML kwam naar voren dat ASML in het belang van productreinheid steeds

meer naar de keten kijkt en streeft naar een nauwere samenwerking tussen hen en de toeleveranciersketen. Alleen als de gehele keten het belang ziet, is een schoon eindresultaat te bereiken. In zijn werk is Bruls met deeltjes tot 4 nm bezig. Hij schets een trend dat terwijl het eindproduct (chips) kleiner wordt, de benodigde machines juist groter worden en er meer mensen nodig zijn. In de machines zijn ook nog meer en sneller bewegende delen aanwezig. Dit alles geeft meer risico op contaminatie en defectivity.
Een van de acties is Contamination Control Management Strategy wat staat voor het verbeteren van ontwerp-, productie- en assemblageprocessen gedurende de hele levenscyclus van het product. Dit vereist meer betrokkenheid bij en een hoger kennisniveau bij leveranciers. Hiervoor is onder andere het nieuwe ASML Cleanliness GSA (Generic Standards van ASML) kader ontworpen, bedoeld om de kennis in de gehele keten over te brengen.


Foto 6: Richard Bruls (ASML): “Een sterke samenwerking tussen ASML en toeleveranciers is nodig om de Contamination Control uitdagingen, voortkomend uit Moore’s Law, het hoofd te bieden.”

Foto 7: Sebastiaan Kummert (Textwipe): “Een wipe lijkt klein maar het gebruik geeft een grote verantwoordelijkheid.”

Foto 8: Harold Veldkamp (Bronkhorst): “Naast definitie van reinheidseis en protocollen is breedgedragen bewustzijn in hele organisatie van belang.”
HET GEBRUIK VAN
EEN CHECKLIST
VAN WIPES VOOR
REINIGING IN EEN CLEANROOM IS GEEN OVERBODIGE
Checklist voor gebruik wipes Het gebruik van een checklist van wipes voor reiniging in een cleanroom is geen overbodige luxe benadrukt Sebastiaan Kummert (foto 7).
De vragen die je moet stellen voordat je de juiste wipe kiest zijn:
• In welke ISO klasse Cleanroom wordt er gewerkt?
• Waarvoor wordt de wipe gebruikt, oppervlakte- of productreiniging?
• Wat zijn de oppervlakte karakteristieken (glad, ruw, etc.)?
• Wat is het materiaal van het oppervlak (RVS, glas, plastic, etc.)?
• Hoe groot is het oppervlak wat moet worden bedekt?
• Welk oplosmiddel wordt gebruikt?
• Wat zijn de karakteristieken van de te verwijderen contaminanten?
Naast deze checklist werd ook ingegaan op het juiste gebruik van wipes.
OPLEIDING VAN BELANG
VCCN zorgt als vereniging voor kennis via richtlijnen en opleidingen. Harold Veldkamp (figuur 8) heeft indertijd als nieuwkomer binnen het vakgebied hier veel aan gehad. Na indiensttreding bij Bronkhorst werd Veldkamp verantwoordelijk voor schoon produceren. In het
proces om hiertoe te komen heeft hij veel geleerd en deelde dit met de aanwezigen. Onder andere een totaalplan schoon produceren. Dit plan bestaat uit:
• breedgedragen commitment in het hele bedrijf;
• focus op het doel;
• een juiste fasering;
• een tijdpad;
• en bewustwording zowel intern als extern.
Voor Veldkamp was het een leerzaam en doorlopend proces van bewustwording, procesbeheersing en gezond verstand gebruiken.
Tijdens de pauze en tijdens het drankje na afloop was er voldoende ruimte om elkaar te ontmoeten en kennis te maken met de getoonde producten bij de bedrijven. De sfeer was gemoedelijk. VCCN kijkt terug op een geslaagd congres.
Voor volgende evenementen en/of cursussen kijk op www.vccn.nl











PBSC MD-Hi
Desinfectie hatch met geïntegreerde
Bioquell waterstofperoxide generator

Bioquell ProteQ
Waterstofperoxide generator voor desinfectie van laboratoria en cleanrooms
Tecnilab-BMI levert reeds meer dan 20 jaar producten en diensten op het gebied van desinfectie oplossingen in de vorm van ruimte desinfectie en/of apparatuur desinfectie. Ook benieuwd wat Tecnilab-BMI voor u kan betekenen? Kijk dan op www.tecnilab-bmi.nl










PBSC MD-Ci
Desinfectie kamer met geïntegreerde
Bioquell waterstofperoxide generator


Bioquell L-4
Waterstofperoxide generator voor desinfectie van equipment en ruimten
Vind o.a. Bioquell en PBSC producten exclusief bij Tecnilab-BMI. We help you move forward. www.tecnilab-bmi.nl
TI24003 - Tecnilab-BMI - Advertentie CCM - 184x124.indd 1 26-02-2024 10:54





























Een persoonlijk- of bedrijfslidmaatschap van VCCN is een absolute ‘must’ voor wie zich beroepsmatig bezighoudt met contamination control. Kortom, een belangrijke toegevoegde waarde binnen jouw vakgebied.
Een greep uit de voordelen van het lidmaatschap:
• Neem deel aan een platform van kennis en ervaring;
• Maak deel uit van een landelijke organisatie met internationale contacten;
• Neem deel aan cursussen tegen een gereduceerd tarief;
• Neem deel aan symposia en excursies tegen gereduceerd tarief;
• Ontvang 4x per jaar het magazine van VCCN;
• Breid je netwerk uit.
NIEUWSGIERIG? BEKIJK ALLE INFO OP ONZE WEBSITE: WWW.VCCN.NL/WORD-LID
MIJN WERK
Projectdirecteur Equans Zuid Nederland BV
De taken die bij mijn werk horen zijn eigenlijk heel makkelijk samen te vatten. Tijd, geld, kwaliteit en veiligheid zijn in de basis de essentie voor een project met een goed eindresultaat. Voeg daar de klant- en medewerkerstevredenheid aan toe en je hebt het totale pakket waarvoor je eindverantwoordelijk bent. Mijn functie bestaat uit het geven van sturing en het faciliteren en borgen van dit pakket. Afhankelijk van de fase waarin een project zit, stem ik mijn dagindeling daarop af. Dat is dus niet in één opsomming samen te vatten.
KENNIS
Mijn stellige overtuiging is dat je als verantwoordelijke voor een project inhoudelijke kennis moet hebben van de techniek die je moet opleveren. In elke fase van het project - budget/prijsvorming, engineering, voorbereiding, uitvoering én eindvalidatiefase - maakt dit het verschil. Uiteindelijk moet ook in elke fase van het project maximaal gepresteerd worden om een goed eindresultaat te borgen. Ik ben trots op het feit dat we het telkens voor elkaar krijgen om met het team alle 28 technische installaties op hetzelfde geplande moment inbedrijf gesteld en gevalideerd klaar te hebben voor de oplevering aan de klant.
Ik houd mijn kennis vooral op peil door het bezoeken van congressen, lezingen, netwerkbijeenkomsten en beurzen. In mindere mate vakbladen en internet. De vakbladen die ik lees zijn van TVVL en VCCN.
GOEDE SFEER TOT AAN DE EINDSTREEP
Wat mijn advies zou zijn aan mensen in mijn vakgebied, is om met beide voeten op de grond te blijven. Iedereen in het project draagt bij aan het succesvol behalen van de eindoplevering. Het enige verschil is de rol die je hebt en de verantwoordelijkheid die daarbij hoort. Een belangrijke les die ik zelf geleerd is dat het de som van alle kleine dingen is die uiteindelijk het grote verschil maken. Uiteraard moet dan wel eerst de basis op orde zijn. Een andere belangrijke les is dat je met alle betrokkenen in een goede sfeer en trots de eindstreep moet zien te halen. Een succesvolle oplevering met een ontevreden projectteam of medewerkers zie ik als falen. Ik hoop dat ik mijzelf over een jaar kan feliciteren met de succesvolle eindoplevering van het High-“Tech” cleanroomproject met opwekkingsgebouw waarmee we in 2022 zijn gestart in Veldhoven.
TRANSITIE NAAR VERDUURZAMING
Ik zie goede mogelijkheden voor energie efficiencyverbetering door variabele recirculatie-voud in de cleanroom. Ik volg deze ontwikkeling nu al enkele jaren, maar zie daar in de praktijk nog niet veel van terug. Als ik dus iets zou mogen veranderen binnen de cleanroom industrie, zou dat daarover gaan. In de transitie naar verduurzaming zie ik namelijk echt kansen voor recirculatie mogelijkheden. Ik ben ervan overtuigd dat de kwaliteit van de cleanroom niet in gevaar hoeft te komen terwijl je kunt besparen op je energieverbruik.

DE SOM VAN ALLE KLEINE DINGEN MAAKT
Cleanroom Schoonmaak Cursus
Woerden
Cleanroom Gedrag Cursus
Woerden
Opfris Cleanroom Gedrag Cursus
Woerden
Opfris Cleanroom Gedrag Cursus
Woerden
Cleanroom Techniek Cursus
Woerden
Cleanroom Behaviour Course
Woerden
Post-hbo Opleiding Contamination
Control & Cleanliness
Woerden
Contamination Control Cursus
Woerden
Cleanroom Reiniging Cursus
Woerden
Opleiding Cleanroom Testen en Certificeren - Belangstellenden en Associate
Woerden
Opleiding Cleanroom Testen en Certificeren - Professional Woerden
Cleanroom Testing and Certify Course
Education / Knowledge / Association
Woerden
Cleanroom Testing and Certify Cours
Professional Woerden
Data onder voorbehoud Bezoek voor meer informatie www.vccn.nl

PM B.V.
PM is een toonaangevende speler in de hightechsector, gespecialiseerd in hoog-nauwkeurige lineaire precisielagers en geavanceerde mechatronische positioneersystemen. Sinds 1966 levert het bedrijf maatwerkoplossingen aan veelal internationale klanten in diverse hightechsectoren en staat bekend om zijn kwaliteit en innovatie. De nauwkeurigheid en betrouwbaarheid van de systemen van PM zijn essentieel in o.a. vacuüm omgevingen waar minimale contaminatie van groot belang is. Of het nu gaat om het minimaliseren van verontreinigingen in de halfgeleiderindustrie of het waarborgen van steriele omstandigheden in de medische technologie, PM’s oplossingen dragen bij aan het behalen van strenge kwaliteitseisen in deze veeleisende sectoren. Voor meer info, bekijk de website PM.nl.
Meprof b.v. Pascalstraat 2 b 7903 BJ HOOGEVEEN www.meprof.nl
Stichting Smart BioMaterials Consortium De Lismortel 31 5612 AR EINDHOVEN www.smartbiomaterials.nl
EFAFLEX- van der Tol en Keijzer B.V. Floridadreef 118 3565 AM UTRECHT www.efaflex.nl
United Logistic Services International (ULSI) B.V. Reflectiestraat 2 2631 RV NOOTDORP www.ulsi.nl
SHIELD Scientific B.V. Costerweg 1 B 6702 AA WAGENINGEN www.shieldscientific.com
VALIDOSS B.V. Minervum 7166 B 4817 ZN BREDA www.validoss.nl
PM B.V. Galileistraat 2 7701 SK DEDEMSVAART www.pm.nl
Rosenberg Ventilatoren en Klimaattechniek BV Elandlaan 8 3437CP DEN DOLDER www.rosenberg.nl
Capable
Weidehek 109 4824 AT BREDA www.capable.nl
Kinetic Analysis B.V.
Topsportinnovatie vindt zijn weg naar de cleanroomwereld via de Kinetic Analysis Group. Het bedrijf, dat dient als innovatie- en inspiratie-lab rondom ‘human motion data,’ werkt met een multidisciplinair team van ontwerpers, hardware- en softwareontwikkelaars, datawetenschappers en domeinexperts, geleid door directeur en eigenaar Maarten Gijssel. Zij implementeren technologie, oorspronkelijk ontwikkeld voor topsport in samenwerking met nationale bonden en Olympische teams, om in cleanrooms de beweegsnelheid van operators te monitoren en hierop in real-time terugkoppeling te geven. Dit vermindert contaminatie en stelt een nieuwe kwaliteitsstandaard in de productieomgeving. Voor meer info, bekijk www.kinetic-analysis.com
Sebastiaan Wolfs
Ik ben Sebastiaan Wolfs uit Rijssen, met een grote interesse in ESD veilige- en schone ruimtes. Bij Romex help ik bedrijven hun kritische processen te optimaliseren. Cleanrooms en ESD veilig werken zijn voor mij de perfecte mix van Hightech innovatie en precisie. Mijn doel: slimme oplossingen koppelen aan menselijk talent en ESD & contamination control naar een hoger niveau tillen.

EFAFLEX
EFAFLEX ontwikkelt en produceert al meer dan 50 jaar hoogwaardige industriële snelloopdeuren, met een sterke focus op toepassingen in cleanrooms en gecontroleerde omgevingen. Dankzij onze innovatieve technologieën, zoals luchtdichte constructies en geavanceerde afdichtingssystemen, helpt EFAFLEX deeltjesvervuiling te minimaliseren en de energie- efficiëntie te verbeteren. De deuren van EFAFLEX combineren snelle openings- en sluitingstijden met maximale afdichting, wat cruciaal is voor gecontroleerde omgevingen. Met decennialange ervaring biedt EFAFLEX op maat gemaakte oplossingen die voldoen aan de strenge eisen van de hightech-, farmaceutische- en voedingsindustrie.
Jaargang 38
editie 1-2025
C2MGZN is een uitgave van VCCN, Vereniging
Contamination Control
Nederland
REDACTIE
Philip van Beek
Arthur Lettinga
Jos Bijman
Veerle van Gent
REDACTIE COÖRDINATIE
Verenigingsbureau VCCN
Korenmolenlaan 4, 3447 GG Woerden
T 088 - 401 06 50 j.bijman@vccn.nl
ADVERTENTIEVERKOOP










Kijk voor advertentietarieven op www.vccn.nl/c2mgzn of mail naar info@vccn.nl
LIDMAATSCHAP VCCN
Persoonlijk lidmaatschap € 52,50 per jaar (incl. btw)
Bedrijfslidmaatschap € 325,- per jaar (excl. btw)
FOTOVERANTWOORDING
Archief VCCN
VORMGEVING EN REALISATIE
Studio Campo
VERANTWOORDING
De realisatie van Contamination Control Magazine is zorgvuldig voorbereid, gepland en uitgevoerd. Desondanks kan VCCN geen verantwoordelijkheid aanvaarden voor eventuele onjuistheden.
COPYRIGHTS
Niets uit deze uitgave mag worden verveelvoudigd en/of openbaar worden gemaakt door middel van druk, microfilm of op welke andere wijze dan ook, zonder schriftelijke toestemming van de uitgever.












MELD JE AAN VIA:















Op woensdag 21 mei organiseren we het jaarlijkse Nationaal Symposium Contamination Control en onze Algemene Ledenvergadering. Ben jij werkzaam in één van de vijf focusgebieden van VCCN - healthcare, micro-elektronica, pharma, food en space - dan mag je dit event niet missen!
Het symposium is door haar brede programma met twee parallelle lezingensessies interessant voor nieuwe én ervaren professionals. De nieuwste technieken en inzichten op het gebied van contamination control en cleanroom technologie staat natuurlijk centraal. We sluiten de dag af met keynote spreker Marcel Levi, internist en hoogleraar Geneeskunde bij Amsterdam UMC.
Buiten het inhoudelijke programma heb je uitgebreid de mogelijkheid om andere professionals te ontmoeten en je te laten bijpraten over de nieuwste technieken en diensten op de bedrijvenmarkt. Wil jij het symposium niet missen? Meld je dan nu aan. We kijken ernaar uit je te ontmoeten op 21 mei 2025 in Gorinchem!
WE SHARE THE KNOWLEDGE!







Met decennia lange ervaring in de cleanroom industrie, zorgen wij voor de beste oplossing voor uw cleanroom. Samen met u, identificeren wij uw behoeften en begeleiden wij u bij het gebruik van de correcte cleanroom kleding en accessoires.
Van het regelen van de voorraad, sterilisatie, levering, onderhoud tot vervanging.
U kan op ons rekenen!
Elis is een internationale multi-service provider voor cleanroom omgevingen met aanwezigheid in 18 landen en 3 continenten.


33 Cleanroom laundry solutions plants
We zorgen ervoor dat gereinigde cleanroomkleding, schoeisel, reinigingssystemen, en andere gerelateerde artikelen, elke dag gebruiksklaar zijn.
Onze artikelen voldoen aan de strengste normen en richtlijnen voor cleanroom omgevingen. Dankzij onze Quality Assurance afdeling zijn de cleanroom artikelen aantoonbaar risicovrij en klaar voor gebruik in uw productieproces.
We zorgen ervoor dat u het maximale kan bereiken.








